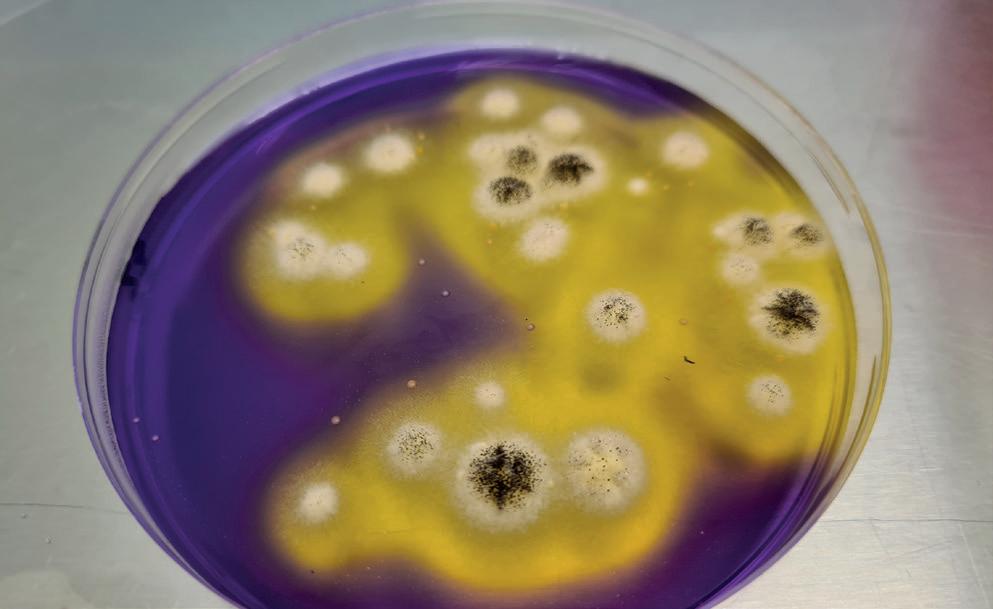
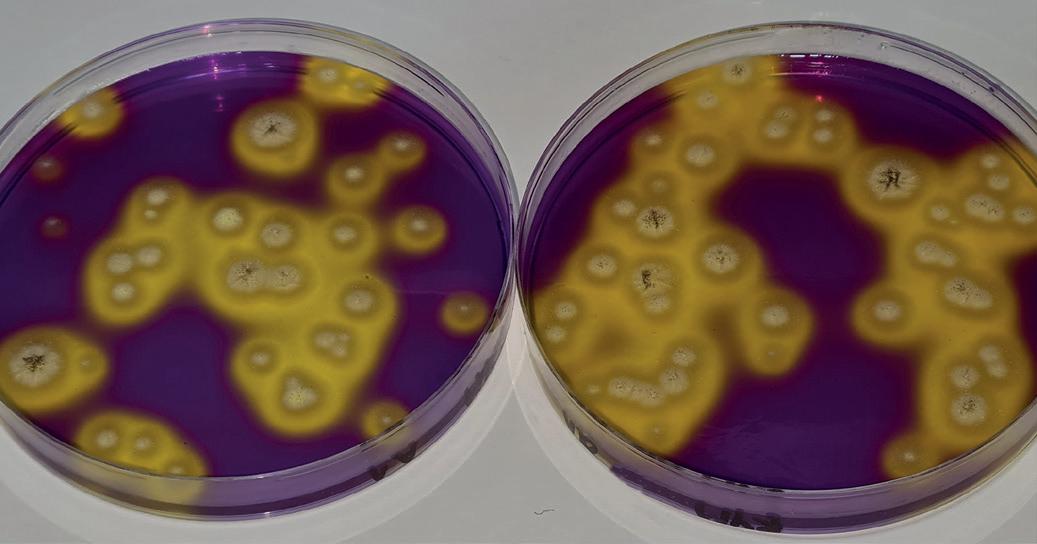
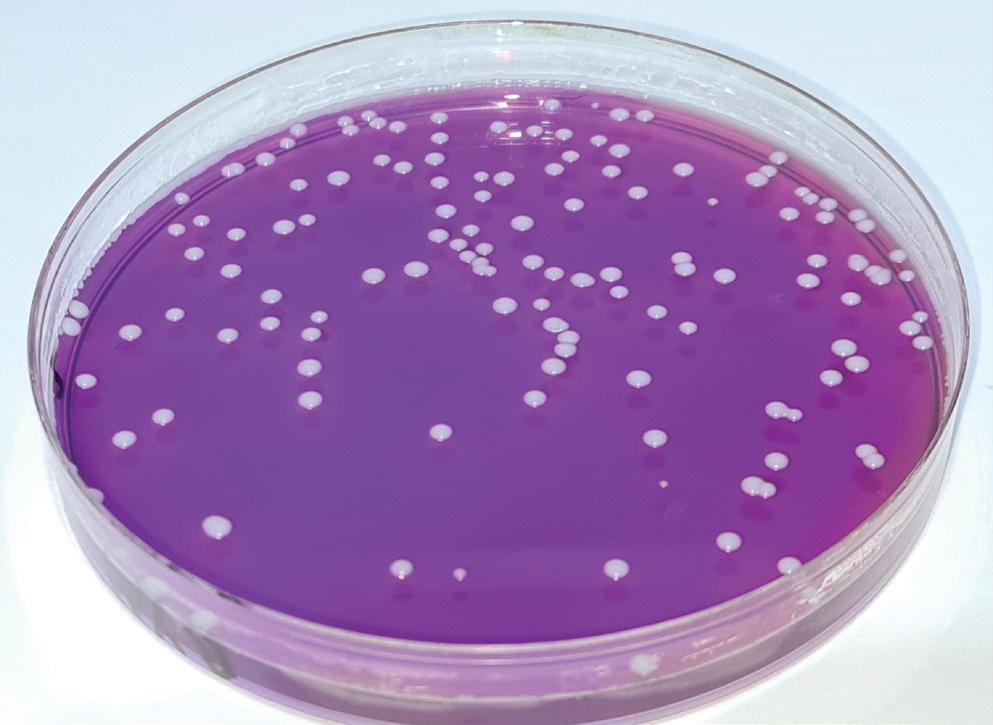
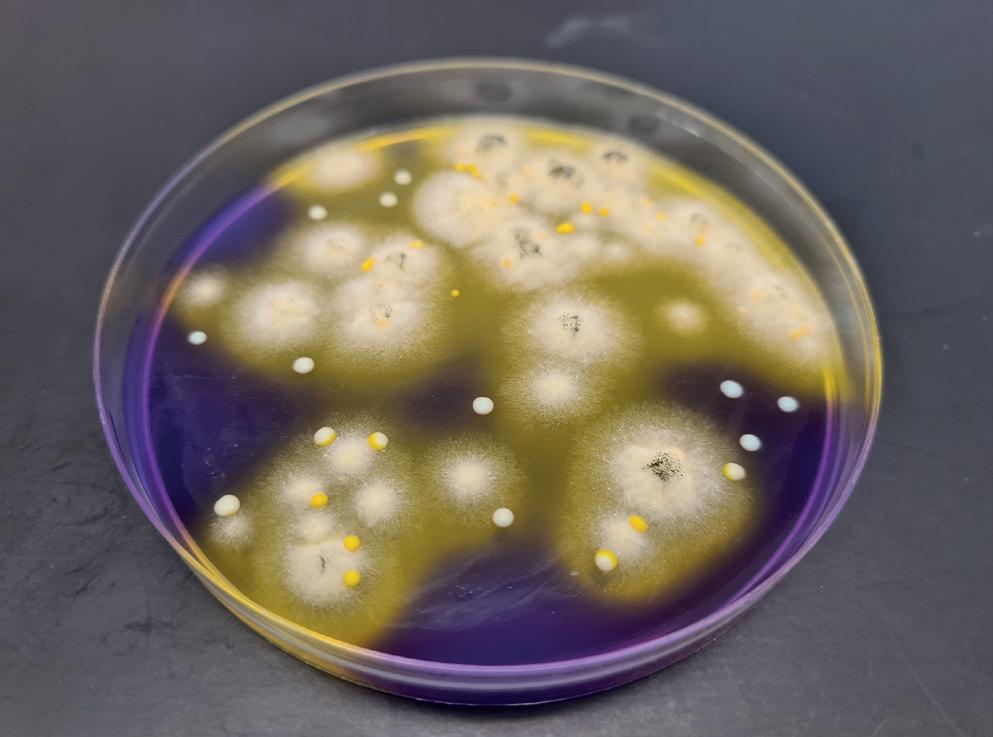

Hacia la temperatura perfecta con la inteligencia artificial
Berlin’s Senator for Economic Affairs Franziska Giffey
visited lab-tech company Knauer


514 pesaje

Pesar con rapidez y precisión




Kern & Sohn GmbH


516 preparación de muestras
Reciclaje de catalizadores de vehículos
Dagmar Klein

técnicas de LABORATORIO 492 Nº 484 SEPTIEMBRE 2023
SEPTIEMBRE
SUMARIO Nº 484
2023
91 702 19 70 / 93 272 04 47)”. hazte fan
“La Editorial a los efectos previstos en el artículo 32.1 párrafo segundo del vigente TRLPI, se opone expresamente a que cualquiera de las páginas de esta obra o partes de ella sean utilizadas para la realización de resúmenes de prensa. Cualquier forma de reproducción, distribución, comunicación pública o transformación de esta obra solo puede ser realizada con la autorización de sus titulares, salvo excepción prevista por la ley. Diríjase a CEDRO (Centro Español de Derechos Reprográficos) si necesita fotocopiar o escanear algún fragmento de esta obra (www.conlicencia.com;
Revista disponible también para:

Ziath ha lanzado una nueva versión de su popular aplicación DP5 Network que permite controlar a distancia lectores y escáneres de códigos de barras desde un teléfono inteligente o tableta a través de una conexión wifi. Gracias a las herramientas de software más recientes, DP5 Mobile ofrece una velocidad y precisión inigualables en la descodificación de gradillas de tubos con códigos de barras, junto con una nueva interfaz de usuario optimizada para dispositivos móviles. DP5 Mobile le liberará de la mesa de laboratorio, permitiéndole utilizar un escáner de tubos en cualquier lugar de su LAN desde su propia tableta o teléfono inteligente, incluso cuando está visitando sus almacenes de compuestos o congeladores. Diseñada para facilitar su uso, la aplicación DP5 Mobile le permite descargar y abrir archivos de resultados, además de compartir estos archivos no solo por correo electrónico, sino también mediante cualquier aplicación de su teléfono o tableta. Para mejorar la productividad, una nueva página de resultados de escaneado reúne todo lo que necesita en una sola pantalla. La funcionalidad especial para dispositivos móviles incluye imágenes de escaneado más grandes, función de zum de imágenes, resaltado de tubos seleccionados, visualización de los resultados exportados automáticamente, así como preguntas y respuestas sobre el tiempo de escaneado.

La aplicación DP5 Mobile es rápida, segura y le permite exportar posiciones y códigos de barras de tubos en más formatos que ninguna otra aplicación: JSON, XLS, CSV, texto, PDF, PNG y Python. Además, también le permite enviar los datos a un compañero o a su PC de sobremesa.
Aunque cualquier lector o escáner basado en cámaras puede actualizarse para ejecutar el software DP5 Standard, actualmente solo los lectores de gradillas con códigos de barras 2D Ziath DataPaq™ Express y DataPaq™ Mirage pueden suministrarse con adaptadores LAN y conectores RJ45 para ejecutar el nuevo software DP5 Mobile.
Si desea más información sobre la DP5
Mobile, visite https://ziath.com/products/upgrade-to-dp5 o comuníquese con la empresa (Tels. +44-1223-855021 / +1-858-880-6920 / +31-6-4314-1195; E-mail. info@ziath.com).
Fundada en 2005, Ziath se especializa en el desarrollo de productos innovadores de control de instrumentación y gestión de la información usando tubos de códigos de barras 2D Data Matrix para simplificar los procesos de automatización en organizaciones de ciencias biológicas, desde el ámbito académico hasta los sectores biotecnológico y farmacéutico. www.ziath.com
técnicas de LABORATORIO 494 Nº 484 SEPTIEMBRE 2023
novedades Novedades
ZIATH
Gestión de muestras en movimiento
Gestión de muestras en movimiento con DP5 Mobile

LUMAQUIN
Instrumentos para realizar mediciones en situaciones especiales
Desde 1976 Lumaquin asesora a sus clientes para controlar la calidad de su producto en todas sus fases. Distribuye equipos y consumibles para laboratorios de calidad de cualquier sector. ElektroPhysik, una de sus marcas representadas, diseña y fabrica una variedad de instrumentos para la medición del espesor de recubrimientos, innovando en la tecnología de control de superficies. Los dispositivos de la serie MiniTest 700, tienen diversas aplicaciones, brindando siempre lecturas precisas. Si lo que necesita es realizar mediciones precisas de difícil acceso, Lumaquin le facilita una idea innovadora, para que pueda ejecutar la medición cómodamente ante situaciones de altura, simplemente adaptando el MiniTest 700 a un dron. La serie MiniTest 700 dispone de tres modelos que se adaptan a las necesidades dependiendo de la forma de medición que desea realizar.

Si necesita uno compacto y económico con sonda interna y hasta 10.000 valores en 10 grupos almacenados, la opción es el Minitest 725. Si prefiere un dispositivo con sonda externa conectada con cable y almacenamiento, también de hasta
RETSCH
Molino
Con el molino planetario de bolas PM 300, Retsch ha añadido un nuevo miembro a su extensa familia de molinos de bolas, que, gracias a sus elaboradas características, facilita el trabajo diario en el laboratorio.
Con una velocidad máxima de 800 rpm, el PM 300 genera una energía de reducción de tamaño extremadamente alta, lo que permite una rápida pulverización de las muestras hasta el rango nanométrico. La unidad compacta de sobremesa admite hasta 4 recipientes de molienda apilables y procesa hasta 440 ml de material de muestra en un solo ciclo de trabajo, cantidad significativamente superior a la que permite cualquier otra unidad de sobremesa.

El funcionamiento de este molino planetario de bolas es espe-
cialmente seguro. El robusto “Safety Slider” garantiza que el molino no pueda ponerse en marcha antes de que el recipiente de molienda esté firmemente sujeto con ayuda del dispositivo de fijación ergonómico. Una característica de seguridad única del PM 300 es una señal acústica y una notificación en la pantalla cuando el dispositivo de fijación se ha fijado con la fuerza requerida de 25 Nm. Para facilitar el proceso, Retsch ofrece una cómoda ayuda de sujeción.
El PM 300 (www.retsch.com/pm300) funciona con la nueva línea de recipientes EasyFit. La función Advanced Anti-Twist garantiza una fijación segura del recipiente de molienda. La geometría modificada de los recipientes de 50 y 250 ml contribuye a acelerar la obtención de la granulometría final deseada. Retsch forma parte de la División Científica del grupo neerlandés Verder. La empresa es un destacado proveedor de soluciones para la preparación de muestras y la caracterización de sólidos de forma neutral al análisis. Basándose en más de 100 años de experiencia, desarrolla innovadores equipos de trituración y tamizado caracterizados por su excelente rendimiento, comodidad de manejo, seguridad y larga vida útil.
Verder Scientific es el paraguas de las empresas QATM (soluciones para materialografía y ensayos de dureza), Retsch (preparación de muestras y análisis de partículas sólidas), Microtrac MRB (sistemas para caracterización de partículas), Eltra (analizadores de combustión para análisis elemental) y Carbolite Gero (hornos de laboratorio e industriales). www.retsch.com
técnicas de LABORATORIO 496 Nº 484 SEPTIEMBRE 2023
novedades
planetario de bolas PM 300: manejo ergonómico y mayor rendimiento
novedades

10.000 valores en 10 grupos, se recomienda el MiniTest 735. Y si lo que quiere es versatilidad, dispone del MiniTest 745, con varias sondas intercambiables, conectables externamente por cable o de forma inalámbrica a través de Bluetooth, con almacenamiento de hasta 100.000 valores en 100 grupos. Si necesita renovar la sonda de su MiniTest o quiere tener varias para distintas precisiones, las imágenes adjuntas muestran los diferentes tipos que hay, adaptadas a la medición que se realice. Para ver la demostración de las mediciones en altura con el Mi-
nitest 700 adaptado al dron, visite su perfil de LinkedIn https:// es.linkedin.com/company/lumaquin


Lumaquin dispone del servicio de asistencia técnica que incluye asesoramiento, calibración, certificación, mantenimiento y servicio posventa.
www.lumaquin.com
(Véase anuncio en la sección Guía del Comprador.)
EMPRESAS
Revvity y Honeycomb Biotechnologies amplían las fronteras de la investigación unicelular
Revvity, en colaboración con la empresa de genómica de célula única Honeycomb Biotechnologies (“Honeycomb”), anuncia el lanzamiento mundial de un conjunto de nuevas soluciones que amplían las fronteras de la biología de célula única:
HIVE™ CLX Single-Cell RNAseq Solution y la plataforma de análisis BeeNetPLUS.
HIVE CLX Single-Cell RNAseq permite una mayor densidad de captura de células individuales, con almacenamiento de muestras integrado en un flujo de trabajo que no requiere instrumentos. Estas características facilitan a los investigadores el estudio de tipos celulares raros y frágiles y permite una mejor comprensión de cómo el sistema inmunitario combate alérgenos y patógenos, además de otras aplicaciones. Es una actualización de la plataforma HIVE de Honeycomb que se lanzó en colaboración con Revvity en 2021.
“La solución HIVE CLX está diseñada para permitir a los investigadores clínicos superar los desafíos que a menudo se encuentran en los estudios de células individuales. Su facilidad de uso en la captura y almacenamiento de muestras amplía tanto el ámbito como el alcance geográfico de la investigación con células individuales, especialmente en áreas como la inmunología innata y las enfer-
medades infecciosas”, asegura Jim Flanigon, CEO de Honeycomb. “Nuestros colegas de Revvity comparten nuestro objetivo de llevar la tecnología de células individuales a un público más amplio, por lo que estamos entusiasmados de ver a nuestros clientes ampliar esos límites con la solución HIVE CLX.”
- Volúmenes de muestra más grandes y seguros. La solución HIVE CLX cuenta con 160.000 micropocillos dentro de un único array de alta densidad que permite recuperar hasta cuatro veces más células por dispositivo en comparación con la solución HIVE™ scRNAseq original. La premisa es que un mayor número de células recuperadas se traduce en un mayor número de transcritos procesados, lo que en última instancia genera datos más fiables y de mayor calidad que repercuten en los avances sanitarios y en los conocimientos biológicos en los ámbitos de la investigación autoinmune, la oncología, la neurología, la biología del desarrollo, la medicina de trasplantes, entre otros.

- Cualquier célula, en cualquier lugar y en cualquier momento. Al eliminar la necesidad de instrumentación especializada, la solución HIVE CLX es idónea para ayudar a los investigadores que trabajan en lugares remotos o con pocos recursos, donde los requisitos de almacenamiento y envío de muestras pueden ser más complejos.
Esto incluye estudios sobre enfermedades infecciosas emergentes o en evolución como el VIH, la malaria, la tuberculosis y la covid-19, así como estudios distribuidos y longitudinales que implican la recogida de muestras en múltiples puntos.
“La capacidad de comprender la salud y la enfermedad humanas a escala unicelular es un gran reto y un objetivo increíblemente importante en la investigación biológica y clínica”, afirma Arvind Kothandaraman, director General de multiómica y diagnósticos especializados de Revvity. “Nos com-
place que la solución HIVE CLX ayude a científicos de todos los ámbitos y niveles de experiencia a acceder a la tecnología RNAseq de célula única.”
- Análisis de datos basado en la nube y servicio de expertos en células individuales. Además de la solución HIVE CLX, Honeycomb ha lanzado su plataforma de análisis basada en la nube BeeNetPLUS que simplifica y acelera la interpretación de datos de los resultados de HIVE CLX. Sin necesidad de codificación ni experiencia en línea de comandos, el flujo de trabajo BeeNetPLUS informa sobre la calidad de la secuenciación, la recuperación de células, genes y transcritos, la anotación del tipo de célula, la expresión diferencial y los gráficos de genes marcadores.
En Revvity, “imposible” es inspiración, y “no se puede hacer” es una llamada a la acción. La firma ofrece soluciones, tecnologías, conocimientos y servicios de ciencias de la salud que proporcionan flujos de trabajo completos desde el descubrimiento hasta el desarrollo, y desde el diagnóstico hasta la curación. Revvity está revolucionando lo que es posible en la atención sanitaria, con áreas de interés especializadas en tecnologías multiómicas traslacionales, identificación de biomarcadores, imágenes, predicción, cribado, detección y diagnóstico, informática y mucho más. Con más de 3.000 millones de dólares de ingresos en 2022 y más de 11.000 empleados, Revvity atiende a clientes de los sectores farmacéutico y biotecnológico, laboratorios de diagnóstico, académico y administraciones públicas. Forma parte del índice S&P 500 y tiene clientes en más de 190 países.
Honeycomb Biotechnologies desarrolla tecnología para eliminar barreras y ampliar las oportunidades del análisis unicelular en la investigación básica, traslacional, preclínica y clínica en todo el mundo. Fundada por destacados científicos del MIT y el Instituto Broad, tiene su sede en Waltham, MA (EE.UU.).
técnicas de LABORATORIO 498 Nº 484 SEPTIEMBRE 2023
novedades
novedades
Serie HDI de electroválvulas
Lee Company ofrece al mercado sus electroválvulas de la serie HDI. Con modelos estándares y biestables, están disponibles en dos y tres vías. Son capaces de alcanzar los de 250 millones de ciclos y hay modelos disponibles con las siguientes características especiales:


• Compatibles con soluciones salinas

• Semiinertes con junta de FFKM
• Para presiones de hasta 3 bar
• Operación silenciosa (menos de 37 dBA).
www.TheLeeCo.com
LEE
La tecnología de etiquetado RFID agiliza la gestión de muestras criogénicas
Ziath anuncia una revolución en la gestión de muestras criogénicas: el lector de gradillas de tubos completo con código de barras 2D RITrack Mirage. Tradicionalmente, identificar la identidad de las gradillas de tubos con código de barras 2D cubiertas de escarcha sacadas del almacenamiento a baja temperatura era un proceso lento y propenso a errores. Basándose en la tecnología patentada de etiquetado de identificación por radiofrecuencia (RFID), el RITrack Mirage puede leer de forma fiable gradillas con códigos de barras 2D cubiertas de escarcha y gradillas tomadas directamente del almacenamiento de nitrógeno líquido en fase de vapor. Se elimina la necesidad de calentar la gradilla para descongelarla (lo que puede degradar las muestras térmicamente sensibles) y así poder leer la identificación de la gradilla de muestras.
Pruebas exhaustivas han demostrado que la tecnología RITrack RFID puede resistir la inmersión y la retirada del nitrógeno líquido en fase de vapor más de 10.000 veces sin perder ningún dato almacenado ni mostrar ninguna degradación física. Por lo tanto, el lector RITrack es el más adecuado para todas las formas de almacenamiento de muestras criogénicas trazables a largo plazo.
Las etiquetas RITrack resisten y funcionan durante toda la vida útil de las gradillas, lo que reduce el coste total derivado de la propiedad y aumenta el retorno de la inversión. El sistema RITrack ha sido diseñado para su uso con consumibles de laboratorio estándar, algo que es beneficioso, ya que elimina la necesidad de comprar costosas gradillas exclusivas. Sencillamente, inserte una etiqueta RITrack en una gradilla de formato SBS existente utilizando una herramienta de inserción de etiquetas fácil de usar. Las etiquetas RITrack encajan de forma cómoda y segura en el espacio interno de casi cualquier gradilla de tubos de formato SBS moldeado.
Los datos de RITrack se almacenan ini-
cialmente en la etiqueta en cuestión de segundos utilizando un lector de gradillas basado en cámara Ziath Mirage equipado con el módulo de antena Ri-Track, que también puede leer los datos de la etiqueta. Después de este almacenamiento inicial de datos, la aplicación Android o Apple DP5 RITrack en un teléfono equipado con NFC permitirá que se lea la información de la etiqueta y se muestren los datos, lo que facilita la identificación de cualquier tubo individual en la gradilla congelada, junto con su ubicación e identidad completa. La lectura de gradillas criogénicas ahora será un proceso tan sencillo como abrir el congelador y retirar una gradilla, y luego presentarla a su teléfono inteligente para ver todos los tubos disponibles en esa gradilla. Este emocionante avance tecnológico elimina la necesidad de transportar gradillas refrigeradas al laboratorio para su lectura. Usando la función ‘Lista de selección’ de la apli-
cación, se podrán verificar los tubos de varias gradillas diferentes delante del congelador, lo que también ahorrará un tiempo valioso al técnico.
Para obtener más información sobre el lector de gradillas de tubos completo con código de barras 2D RITrack Mirage, comuníquese con la empresa (+441223-855021 / +1-858-880-6920 / +31-6-4314-1195 / info@ziath.com).
Ziath está especializada en el desarrollo de instrumentos y software innovadores para la gestión de muestras utilizando tubos con código de barras 2D Data Matrix. Estos productos se usan mucho en organizaciones académicas, biotecnológicas y farmacéuticas. Como parte de la división de Consumibles e Instrumentos Científicos de Azenta Life Sciences (Chelmsford, MA), la empresa ocupa un lugar idóneo para respaldar a los clientes en todo el mundo.
www.ziath.com

técnicas de LABORATORIO 500 Nº 484 SEPTIEMBRE 2023
novedades
ZIATH
Lector de gradillas de tubos completo con código de barras 2D RITrack Mirage
novedades
Microválvulas para microdispensación

Lee presenta la serie VHS de microválvulas para microdispensación. Fieles a su lema “innovación en miniatura”, estos componentes de tan solo 5,6 mm de diámetro presentan las siguientes características:

• Dos vías N.C.
• Frecuencia de operación de hasta 1.200 Hz
• Resolución del volumen dispensado de hasta 10 nL

• Tiempo de respuesta de 0,25 ms
• Gran variedad de conexiones disponibles.
www.TheLeeCo.com
LEE
AUXILAB
Centrífugas Nahita-Blue: innovación y eficiencia en el laboratorio
La centrifugación es una técnica fundamental en la investigación científica. Permite separar componentes de una muestra en función de su densidad y tamaño. En respuesta a las necesidades emergentes de la comunidad científica, Auxilab presenta la nueva gama de centrífugas Nahita-Blue, que se ha reestructurado y ampliado para brindar mayor versatilidad y rendimiento. Los nuevos modelos HICAP+ 2761, Medibas+2741 y Multibas+2751 en la categoría de baja velocidad, junto a los modelos 2811 y 2821 en la categoría de alta velocidad, ofrecen características mejoradas y opciones de refrigeración para satisfacer una variedad de aplicaciones. El modelo 2771R destaca por su versatilidad: en función del rotor que tenga el equipo sirve para baja o alta velocidad. La detección del rotor es automática mediante un sensor que incorpora la propia centrífuga. Veamos las características, comportamiento y utilidades de estos equipos de vanguardia.
Esta gama de centrífugas incorpora la última tecnología en sistemas de rotación, lo que permite alcanzar velocidades más altas y tiempos de centrifugación reducidos. Esto se traduce en una mayor eficiencia y productividad en el laboratorio. Estos equipos ofrecen una amplia variedad de capacidades de carga, desde microcentrífugas de alta velocidad hasta centrífugas de gran capacidad para tubos de mayor volumen. Además, se han diseñado rotores especializados que permiten centrifugar diferentes tipos de muestras, desde células sanguíneas hasta preparaciones proteicas.
Están diseñadas para minimizar el ruido y las vibraciones durante su funcionamiento, lo que proporciona un entorno de trabajo más cómodo y seguro. Entre las utilidades de estas centrífugas cabe citar:
1. Biología molecular y genética: en estudios de biología molecular y genética, son ideales para preparar muestras, separar ácidos nucleicos y purificar proteínas.
2. Investigación médica y diagnóstico: En el ámbito clínico, son fundamentales para procesar muestras de sangre, orina y otros fluidos biológicos, acelerando el diagnóstico y tratamiento de enfermedades.
3. Bioquímica y proteómica: Para la caracterización de proteínas y análisis bioquímicos, la nueva gama de centrífugas permite obtener resultados precisos y reproducibles.
4. Industria farmacéutica y biotecnológica: En la producción y
control de calidad de medicamentos y productos biotecnológicos, estas centrífugas son indispensables para la purificación y separación de productos químicos y biomoléculas. Estas centrífugas representan un avance significativo en la tecnología de laboratorio, proporcionando una combinación única de características, rendimiento y versatilidad. Con su precisión, eficiencia y seguridad, estos equipos se convierten en aliados indispensables para los técnicos de laboratorio en una amplia variedad de aplicaciones científicas y médicas.
Tabla comparativa de características
Biología
La nueva gama de centrífugas representa un avance significativo en la tecnología de laboratorio, proporcionando una combinación única de características, rendimiento y versatilidad. Con su precisión, eficiencia y seguridad, estos equipos se convierten en aliados indispensables para los técnicos de laboratorio en una amplia variedad de aplicaciones científicas y médicas.

www.auxilab.es
(Véase anuncio en la sección Guía del Comprador.)
técnicas de LABORATORIO 502 Nº 484 SEPTIEMBRE 2023
novedades
Velocidad Capacidad Aplicaciones Modelo máxima máxima Refrigeración clave (rpm) (ml)
celular, 2771R 18.000 1.000
mLx4)
2761 6.000 2.000
400 mL Investigación clínica, Medibas+2741 6.000 (50 mLx8/ Sí
100 mLx4)
6.000 480 mL Sí Bioquímica, análisis (15 mLx32)
2811 16.000 400 mL Sí Biología celular, (100 mLx4) virología 2821 18.000 50 mL No Microbiología, (5 mLx10) inmunología
virología, (250
Sí investigación clínica y diagnóstico HICAP+
Sí Biología molecular, (500mLx4) genética
diagnóstico
Multibas+2751
de proteínas
VWR
Disolventes en bidones retornables
VWR® ofrece al mercado HiPerSolv ChromaNorm® HPLC, gama de disolventes en bidones retornables.

Características:
La pureza del producto cumple con las muy competitivas especificaciones de VWR
Diferentes grados para sus requisitos especiales
El sistema de sellado reduce las posibilidades de contaminación
El recipiente y los accesorios de acero inoxidable de alta calidad permiten un control de disolvente sencillo y limpio.
Conveniencia:
La reutilización contribuye a eliminar residuos
Se necesita mucho menos espacio de almacenamiento que el mismo volumen en botellas
novedades
Sin gastos derivados de la eliminación de envases peligrosos
Operación presurizada con gas inerte o presión manual
Posibilidad de conexión directa a las líneas de producción
Opción de contenedor disponible con seguridad adicional y características de conveniencia
Se reduce la exposición del personal a vapores inflamables o nocivos.
Seguridad:
Opción de contenedor disponible con seguridad adicional y características de conveniencia
Se reduce la exposición del personal a vapores inflamables o nocivos.
VWR, canal de distribución de Avantor, brinda acceso a soluciones de servicios y productos de misión crítica en industrias
de life science y otras industrias reguladas, que incluyen: farmacéutica, biotecnología, educación, gobierno, salud y tecnologías avanzadas.
Avantor es un socio global de confianza para clientes y proveedores en las industrias de life science, tecnologías avanzadas y materiales aplicados.
es.vwr.com

Fluidos y medios de cultivo para pruebas de esterilidad (método de filtración por membrana) de productos farmacéuticos
- Fluido K, diluyente utilizado para la homogeneización de muestras para examen microbiológico
- Fluid A y Fluid D, fluidos de enjuague y/o dilución utilizados para los métodos de filtración por membrana
- Caldo de tioglicolato y caldo de soja tríptica (TSB), medio líquido altamente nutritivo utilizado para pruebas de esterilidad.
- Frasco de boca ancha disponible. Frascos con dos o tres envoltorios disponibles bajo pedido. Las formulaciones cumplen los requisitos del método armonizado en Estados Unidos (USP), Europa (EP) y la Farmacopea Japonesa (JP).

es.vwr.com
UNICOOS
Vídeo
Feique, Foro Química y Sociedad, del que ANQUE es parte integrante, y el canal educativo Unicoos, han publicado el trigésimo vídeo de la colección #UniQoos con Química con el título “Y así se obtiene el cobre, el metal inmortal”, en el que en poco más de 10 minutos se habla de uno de los metales más importantes para la humanidad: el cobre, que forma parte de nuestra vida diaria al estar presente en innumerables aplicaciones: desde componentes electrónicos a edificios emblemáticos o, incluso, en los alimentos que consumimos.
Este metal se considera “inmortal” ya que el 80% que se ha extraído en los últimos 10.000 años sigue todavía en uso, pues se puede reciclar infinitamente.
Para conocer con más detalle su proceso, tratamiento y aplicaciones, David Calle y su equipo han viajado hasta las instalaciones de Altantic Copper en Huelva, la mayor empresa de producción de cobre refinado de alta pureza en España y una de las más importantes del mundo,. El vídeo explica cómo se lleva a cabo la electrólisis a escala industrial, así como el papel fundamental que desempeña también este metal en la descarbonización y la transición energética.

El proyecto audiovisual #UniQoos con Química es una iniciativa educativa y de colaboración entre Feique, Foro Química y Sociedad y Unicoos, el principal canal educativo de YouTube en España y tercero en el mundo por número de visitas y suscriptores, dirigido por el profesor, youtuber y divulgador científico David Calle. Arrancó en 2019, en el marco de la celebración del Año Internacional de la Tabla Periódica, para acercar la química al público más joven e impulsar su curiosidad por esta ciencia
e industria desde su ámbito más práctico, así como destacar el importante papel que desempeña la química en nuestra vida cotidiana para alcanzar un futuro sostenible, más igualitario y justo para todos, teniendo en cuenta las necesidades ambientales del planeta.
Desde su estreno en 2019, #UniQoos con Química ha conseguido más de 17 millones de impresiones en redes sociales en los diferentes perfiles por los que se difunde a través de Unicoos, Feique y Foro Química y Sociedad (Youtube, Twitter, LinkedIn, Instagram y Facebook) y suma casi medio millón de visualizaciones directas a través del canal de Unicoos en YouTube, vía por la que se han estrenado una treintena de capítulos.
www.anque.es / www.unicoos.com
técnicas de LABORATORIO 504 Nº 484 SEPTIEMBRE 2023
novedades
VWR
de UniQoos con Q de Química “Y así se obtiene el cobre, el metal inmortal”
novedades

HACH
El color para pharma – LICO 690
En la farmacopea estadounidense USP, la medida de color se definió hace años según el sistema colorimétrico CIE-Lab (ASTM Z 58.7.1 e ISO 11664). En Europa, sin embargo, estas pruebas se realizan mediante la coincidencia visual de colores, de acuerdo con la Farmacopea Europea (EP o PharmaEur).

Con la publicación de la edición EP 10.3 a principios de 2021, la medida fue implementada con un nuevo método III, para el color en muestras líquidas de forma instrumental.
Hach lanzó su primer LICO en 1994 y desde entonces no ha dejado de evolucionar hasta llegar a los actuales LICO 690 que almacenan los 37 valores de referencia CIE-Lab.
Las características destacadas del equipo son:
- Reconocimiento automático de cubeta 10, 11 y 50 mm
- Volumen de muestras de solo 3 a 5 ml
- Conforme a GLP
- 26 escalas de color
- Capacidad de almacenamiento de 3.000 valores y 100 valores de referencia.
www.es.hach.com
(Véase anuncio en la sección Guía del Comprador.)
novedades
TESTA
Automated software for HPLC pump validation
Testa Analytical Solutions e.K. has launched a new software tool for its AB4000X range of flowmeters enabling labs to automatically validate the performance of HPLC, uHPLC and GPC/SEC pumps. The Pump Validation Software Suite has been designed to accept raw data generated by the Testa Analytical flowmeter PC-App and perform all necessary flow calculations automatically. Using this powerful software tool - all data and parameters are automatically validated for fitness of use for validation and a summary report generated which can be stored or printed for hard copy documentation. This powerful software tool comes with a Standard Operating Procedure (SOP) detailing the whole validation protocol. In addition, this new software can also be used to calculate ancillary pump performance parameters, such as real-time pulsation, which can be used to identify
transient changes in pump performance. The AB4000X flowmeter range from Testa Analytical sets the benchmark for realtime monitoring devices for continuously measuring the performance of pumps serving HPLC, uHPLC, LC/MS, GPC/SEC, and flow chemistry systems. Compatible with all common solvents, the compact AB4000X flowmeter powers itself from a USB connection. At the heart of each Testa flowmeter is a high-resolution thermal flow sensor that is both extremely accurate and sensitive. This non-invasive sensor enables the device to operate over a wide dynamic range. Each TESTA flowmeter is supplied with an easy-touse PC based App that allows users to continuously record, and store measured flow rate data from a HPLC system. Current flow rate is displayed on the devices integral high-resolution OLED display. For further information please visit https://www.testa-analytical.com/hplc-

chromatography.html or contact Testa Analytical Solutions (+49-30-864-24076 / info@testa-analytical.com).
Testa Analytical Solutions is a leading specialist supplier of liquid chromatography instruments and detectors. Drawing upon over 30 years’ experience, Testa Analytical Solutions has established itself as a respected creator and supplier of top quality, innovative, high performance chromatography instrument kits, and detectors with OEM clients around the world.
www.testa-analytical.com
BIOTECH FLUIDICS
Reliable, high-performance connections for UHPLC instruments
Biotech Fluidics has published a practical review paper that demonstrates how its MarvelX™ and MarvelXACT™ high pressure fluidic connections enable users to achieve reliable, repeatable, and consistent UHPLC performance. In this paper, fluidic experts explore the connection challenges facing users of modern UHPLC instruments. One of the biggest challenges in designing high performance fluidic connections for
UHPLC is ensuring a reliable seal at the bottom of the connection port. The novel design of MarvelX™ and MarvelXACT™ reduces the sealing area needed to make a connection capable of withstanding UHPLC pressures and significantly decreases the amount of force needed to properly install a connection.
Data is shown that demonstrates how the unique design of MarvelX™ and MarvelXACT™ fittings simplifies and speeds installation without sacrificing high performance. By changing the sealing mechanism and drastically decreasing required installation force, MarvelX™ and MarvelXACT™ fittings also remove the potential to damage critical UHPLC instrument components.
Benefiting from a torque limiting mechanism that ensures fittings cannot be overtightened, data is shown that

shows how MarvelXACT™ highpressure fluidic fittings enable users to achieve repeatable and consistent performance at pressures up to 19,000 psi even after 100 repeat uses. By simplifying and speeding installation without sacrificing high performance even after many repeat uses, and eliminating damage to UHPLC instruments components, MarvelX™ and MarvelXACT™ fittings potentially provide UHPLC labs with savings of thousands of euros per year. To download this review paper please visit http://www.biotechfluidics.com/wpcontent/uploads/2023/08/White-PaperReliability-of-Next-Generation-UHPLCConnections.pdf or contact Biotech Fluidics (+ 46 300 56 91 80 / + 612-7035718 / info@biotechfluidics.com).
www.biotechfluidics.com
técnicas de LABORATORIO 506 Nº 484 SEPTIEMBRE 2023

novedades
ORTOALRESA
Lanzamiento de la centrífuga Digicen 22 con sistema REI y conectividad
Las pantallas TFT de Ortoalresa llegan a las centrífugas universales. Con el lanzamiento de la nueva serie Digicen 22, la usabilidad y funcionalidad de las pantallas TFT también estará disponible en equipos medianos.
Este equipo, universal por concepto, está provisto de una amplia gama de rotores que permiten trabajar con microplacas, criotubos, microtubos y adaptadores para tubos de diversos tamaños. La pantalla táctil facilita la configuración y el control preciso de las diferentes funciones y parámetros del equipo y permite, además de las funciones estándares, alternativas con un alto grado de especialización a nivel técnico, como programar el momento en el que ha de comenzar el ciclo (Start Delay), la consecución en cadena de diferentes programas (Linked Program) y sus 100 memorias programables con protección bajo contraseña.

Pero este lanzamiento viene acompañado de más novedades, como el sistema REI (Rotor Easy to Install) y la conectividad. El nuevo sistema REI (Rotor Easy to Install) de Ortoalresa para un intercambio rápido y sencillo de rotores, permite instalar el rotor y bloquearlo de forma segura sin necesidad de herramientas, así como desbloquearlo con solo retirarlo de su posición. Gracias a su diseño ergonómico, puede manejarse cómodamente con una mano. En solo unos segundos sustituya su rotor posicionándolo en el eje del motor y quedará automáticamente anclado gracias al sistema REI. Para retirarlo, levante del tirador rojo: el sistema REI se liberará y permitirá retirar el rotor.
Otra de las novedades de esta gama de equipos es la conectividad, que permitirá al usuario gestionar la información y el rendimiento de su centrífuga desde un dispositivo con conexión a Internet. Gracias a la aplicación gratuita Ortoalresa SmartCon-
nect, se podrá consultar, programar y controlar la centrífuga desde el dispositivo que elija (PC, tablet y teléfono móvil), solo habrá que conectar la centrífuga a la red wifi del laboratorio. Con el lanzamiento de la nueva serie Digicen 22, Ortoalresa ha logrado ofrecer una solución completa y versátil para el procesamiento de muestras. El sistema REI proporciona un intercambio rápido y seguro de rotores sin necesidad de herramientas, mejorando la comodidad y la productividad. Y gracias a la conectividad a través de la aplicación Ortoalresa SmartConnect, los usuarios pueden gestionar y controlar su centrífuga de forma remota, brindando mayor flexibilidad y accesibilidad.
www.ortoalresa.com
(Véase anuncio en la sección Guía del Comprador.)
Cámaras para microscopio
Las cámaras para microscopio de Kern pueden emplearse de forma universal y conectarse fácilmente, a través de USB, al microscopio y a un ordenador de sobremesa o portátil.
La prestigiosa técnica CMOS favorece la rápida obtención de imágenes de gran nitidez.
El software (en inglés) incluido en el envío ofrece una buena documentación básica sobre observación y medición
para todas las aplicaciones más habituales de la microscopia que facilitará el trabajo al usuario. El envío incluye:
- Cámara
- Cable USB
- CD con software
- Micrómetro de objetos para la calibración
- Datos técnicos: USB 2.0;
3 MPX (cámara 5.0 MPX disponible); para Win XP, 7, 8 y 10.
www.kern-sohn.com
(Véase anuncio en la sección Guía del Comprador.)

técnicas de LABORATORIO 508 Nº 484 SEPTIEMBRE 2023
KERN
INTEGRA
Dominio de la repetibilidad en el cultivo celular con la bomba peristáltica dispensadora Welljet
El dispensador de reactivos Welljet de Integra Biosciences y los casetes de dispensación EasySnap™ ofrecen una solución única a los problemas comunes en los flujos de trabajo con células, empleando tecnología de bomba peristáltica para una dispensación suave que minimiza el estrés por cizallamiento en muestras de células frágiles y mantiene una alta viabilidad. El cultivo celular es una potente herramienta para estudiar los procesos biológicos complejos, y es un importante proceso en la investigación, desarrollo y producción farmacéutica. La tecnología de bomba peristáltica del dispensador Welljet ayuda a mantener la viabilidad celular ofreciendo una dispensación suave con bajas fuerzas de cizallamiento. Además, el líquido se mantiene dentro del sistema de tubos de la bomba, lo que evita de forma inherente la contaminación de la muestra para obtener resultados más fiables y reproducibles. Las velocidades de dispensación y el volumen pueden ajustarse para optimizar cada experimento y obtener los mejores resultados posibles, a la vez que un apilador de dispensadores opcional permite a los científicos automatizar el llenado de placas para obtener un mayor rendimiento de las muestras y reducir la variabilidad manual. El dispensador y el apilador de dispensadores Welljet ocupan el menor espacio posible para los instrumentos de su clase, ahorrando un valioso espacio y permite colocar los instrumentos en una cabina de flujo laminar. El Welljet está especialmente diseñado para llenar o añadir reactivos a las microplacas, ofreciendo una flexibilidad total para la dispensación en todos los formatos de microplacas, de 6 hasta 1.536 pocillos. Las placas de cultivo celular con tapa pueden procesarse de forma rápida y fiable sin intervención manual, gracias a la función de manipulación de tapas del apilador. El sistema emplea casetes de dispensación EasySnap fáciles de instalar, que incorporan tubos de silicona moldeados por inyección y diseñados para mantener un diámetro interior constante con un alto grado de precisión y exactitud. Los casetes pueden cambiarse rápidamente entre diferentes experimentos, y pueden esterilizarse fácilmente enjuagándolos con etanol al 70% o esterilizándolos en autoclave. Estas caracte-
El dispensador de reactivos Welljet minimiza el estrés por cizallamiento para una mayor viabilidad celular, y el apilador dispensador ofrece llenado automático de placas para un mayor rendimiento y reproducibilidad
rísticas hacen de la combinación del Welljet y de los casetes EasySnap una valiosa herramienta de laboratorio para ayudar a los investigadores a aumentar la productividad y agilizar sus flujos de trabajo de cultivo celular.

Integra Biosciences provee herramientas y consumibles de laboratorio de alta calidad para la manipulación de líquidos y la preparación de medios. La firma está comprometida con la creación de soluciones innovadoras que satisfagan las necesidades de sus clientes en la investigación, el diagnóstico y el control de calidad dentro de los mercados de las ciencias de la vida y del sector médico. Los productos innovadores de Integra se utilizan hoy en todo el mundo. Más de 100 socios de distribución cuentan con el apoyo de un equipo de especialistas motivados y experimentados en las sedes de la empresa en Zizers (Suiza) y Hudson (New Hampshire, EE.UU.). Integra es una empresa con certificación ISO 9001.
www.integra-biosciences.com

novedades
Hacia la temperatura perfecta con la inteligencia artificial
Lauda pone en marcha un proyecto de investigación sobre inteligencia artificial en colaboración con la Universidad de Aalen.
Lauda Dr. R. Wobser GmbH & Co. KG colabora con el IAA (Instituto para la Técnica de Propulsión) de la Universidad de Aalen en el desarrollo de un sistema de pronóstico y gestión de la salud (PHM, Prognostics and Health Management) para el control del estado basado en inteligencia artificial (IA) de equipos de termorregulación en bancos de pruebas de automóviles. El Ministerio de Economía, Trabajo y Turismo de Baden-Württemberg, en el marco del programa de financiación InvestBW, respalda este proyecto con una aportación de 424.000 EUR. Lauda, líder mundial en el sector de la regulación exacta de la temperatura, seguirá avanzando en la digitalización de la técnica de regulación de temperatura en los productos digitales de Lauda.Live gracias a este proyecto y facilitará a los clientes una solución innovadora para aumentar la vida útil, fiabilidad y rendimiento de los equipos de termorregulación de Lauda.
Las pérdidas de producción y retrasos debidos a interrupciones del funcionamiento pueden limitarse e incluso evitarse con ayuda de un mantenimiento preventivo y predictivo (Predictive/Preventive Maintenance) asistido por IA. Además, con el aprendizaje automático es posible desarrollar estrategias ope-
Logotipo del programa de financiación InvestBW (©InvesBW)

rativas eficientes, como el transporte de flujo optimizado, según cada aplicación.
“El desarrollo de la inteligencia artificial y las posibles soluciones resultantes avanza exponencialmente”, explica el Dr. Marc Stricker, director General de Lauda. “El innovador proyecto de investigación y la estrecha colaboración con la Universidad de Aalen nos permiten seguir nuestro exitoso camino, el de la digitalización de la técnica de regulación de la temperatura, de manera consecuente y, sobre todo, en continuo diálogo. En la actualidad, la inteligencia artificial debe integrarse en las soluciones y ofrece un potencial enorme de optimización”.
técnicas de LABORATORIO 510 Nº 484 SEPTIEMBRE 2023 I+D
El equipo de proyecto Lauda está compuesto por miembros interdepartamentales de las áreas de investigación y desarrollo, servicio técnico y gestión de productos con el fin de garantizar la experiencia necesaria para estudiar las causas de los fallos, los sensores y los datos para una investigación y modelación posteriores en la Universidad de Aalen. Está previsto que el proyecto surgido de la red “DigiServ” finalice en marzo de 2025. Digi-Serv es una red de innovación y desarrollo que se ha puesto como objetivo estructurar y automatizar los procesos en el área de servicios.

Lauda.Live
El líder mundial en el sector de la regulación exacta de la temperatura agrupa bajo Lauda.Live una serie de nuevos productos digitales. Todas las soluciones de regulación de temperatura y de laboratorio de Lauda son equipos IoT completamente conectados en red e inteligentes. Lauda.Live ofrece amplias funciones de gestión de flotas, herramientas inteligentes de análisis y supervisión, así como sofisticadas funciones de control y mantenimiento remoto que maximizan el tiempo de funcionamiento, la fiabilidad y el rendimiento de todos los equipos de Lauda. Encontrará más información
al respecto en https://www.lauda.de/de/temperiergeraete/ digitale-produkte
Lauda
“Somos Lauda, líderes mundiales en el sector de la regulación exacta de la temperatura. Nuestros equipos e instalaciones de termorregulación son la parte fundamental de aplicaciones importantes y contribuyen a mejorar el futuro. Somos un proveedor integral y garantizamos la temperatura óptima en la investigación, la producción y el control de calidad. Somos el socio en el que confiar para la electromovilidad, el hidrógeno, las industrias química, farmacéutica/biotecnológica y de semiconductores, así como la de la tecnología médica. Gracias a nuestro asesoramiento competente y a unas soluciones innovadoras, llevamos más de 65 años entusiasmando cada día de nuevo a nuestros clientes de todo el mundo.
En la empresa también vamos siempre un paso por delante. Impulsamos a nuestros empleados y nos desafiamos constantemente: por un futuro mejor que forjamos juntos.”
www.lauda.de
técnicas de LABORATORIO 511 Nº 484 SEPTIEMBRE 2023 I+D
El grupo de investigación para la supervisión de estado controlada por IA en su puesta en marcha en la sede central de Lauda en Lauda-Königshofen (©Lauda)
Berlin’s Senator
for Economic
Affairs Franziska Giffey visited lab-tech company Knauer
The management of Knauer Wissenschaftliche Geräte GmbH had the honor of welcoming Berlin’s Senator for Economic Affairs, Ms. Franziska Giffey (SPD), and State Secretary Michael Biel to the company’s headquarters on June 14. The visit was part of the “Made in Berlin” event series initiated by Ms. Giffey’s predecessor Mr. Stephan Schwarz.

Continuing this tradition of visiting manufacturing companies, Senator Giffey is seeking dialogue with the managers and their employees to make Berlin’s dynamic and innovative economy more visible and to discuss its needs and development in talks on site. Ms. Giffey used the visit to acknowledge Knauer’s commitment and innovations and to engage directly with the workforce. She was given an insight into the strategies and production processes that enable the company to bring cutting-edge technologies to the market.
Thomas Müller, head of production at Knauer, gave an interesting insight into mechanical production and instrument assembly during a tour, while Dr. Ulrike Krop, application expert at Knauer, informed the visitors about the instruments and applications in the laboratory. Cutting-edge technology and support for those who develop it further must go hand in hand to be
técnicas de LABORATORIO 512 Nº 484 SEPTIEMBRE 2023 companies
From left, Franziska Giffey, Alexandra Knauer, Carsten Losch, Michael Biel, Roswitha Knauer with IJM system (Photos: Knauer)
successful in the competitive laboratory market.
“It is a great honor for us to welcome Senator Giffey and State Secretary Biel here at Knauer,” said Managing Director Carsten Losch. “We are pleased to have the opportunity to show our company and talk to the Senator about our challenges and successes.”
The visit began with a round of talks, during which the senator and her state secretary were informed by the managing directors and the founding couple about the company’s growth, product range and latest business field. For her part, the senator spoke about her priorities in her new office and was particularly interested in the IJM systems developed during the Corona pandemic to produce lipid nanoparticles, which are important for mRNA vaccines. BioNTech’s Corona vaccine Comirnaty is produced using these novel systems from Knauer. Knauer was honored for its innovative achievements as a “Vorsprung” award winner at the East German Business Forum in Bad Saarow on June 11.
Surprisingly for Senator Giffey, many Knauer employees were waiting in the
company courtyard when she left. She enthusiastically praised the employees: “Great example of Berlin’s economy, with innovative strength and the great products that represent Berlin in the world.” For the finale, there was still a joint photo.
The visit provided an ideal opportunity for a productive exchange about the
current challenges not only in terms of decarbonization and skills shortages, but also about the opportunities and strengths of Berlin’s SME sector and underlined Knauer’s commitment to innovation, quality, and local production.

The company
Based in Berlin-Zehlendorf, Knauer develops and manufactures laboratory equipment for the life science, pharmaceutical, biotechnology, chemical, environmental and food industries. The company is best known for liquid chromatography systems and components, but also played a crucial role in the production of lipid nanoparticles for mRNA corona vaccines with its newly developed equipment. Company owner Alexandra Knauer manages the family business together with Carsten Losch. Both are committed to sustainable and responsible corporate governance with a focus on the users, the 190 employees and society.
www.knauer.net

técnicas de LABORATORIO 513 Nº 484 SEPTIEMBRE 2023
companies
(Véase anuncio en la sección Guía del Comprador.)
Dr. Ulrike Krop (left) shows Senator Franziska Giffey a Knauer liquid chromatography system
Production employee Eloi Yepes-Asens (right) shows Franziska Giffey and Micheal Biel the electronic production guide
Pesar con rapidez y precisión
Kern & Sohn GmbH lanza una nueva balanza de análisis que aúna la elevada precisión y fiabilidad con la rapidez de resultados.

La balanza de análisis ABP-A está basada en una célula de pesaje de la nueva generación Single-Cell de una aleación de aluminio. Esta célula fabricada de una sola pieza, con un breve intervalo de estabilización y gran resistencia a las temperaturas, destaca por indicar el resultado del pesaje considerablemente más rápido que otros sistemas de pesaje. Esta característica, junto al menú configurado intuitivamente y una cruz de navegación, permite trabajar de forma efectiva.
Un valor estable en un instante
Las tres puertas correderas automáticas de la balanza, que se pueden abrir y cerrar mediante sensores o, alternativamente, pulsando un botón, contribuyen a acelerar el proceso de pesaje. El sistema automático, además, previene la contaminación por una apertura manual. El parabrisas ajustable interno de altura regulable reduce al mínimo las influencias ambientales en el interior de la zona de pesaje, con lo que se consigue una mayor estabilidad del valor de pesaje. Con ello, la pantalla indica sin demora unos resultados fiables.
técnicas de LABORATORIO 514 Nº 484 SEPTIEMBRE 2023 pesaje
Kern & Sohn GmbH
Figura 1: La balanza de análisis Kern ABP-A aúna una elevada precisión y fiabilidad con unos rápidos resultados; está basada en una célula de pesaje de la nueva generación Single-Cell
Ajuste automático y lectura precisa
El sistema interno de ajuste automático, entre otros, asegura la precisión y fiabilidad: La balanza se ajusta de nuevo automáticamente en caso de cambios de temperatura de más de 1 °C y en función del tiempo, cada cuatro horas. De este modo obtiene siempre una elevada exactitud y le permite al usuario usarla en cualquier lugar. En función de la versión del modelo, Kern ABP-A alcanza una precisión de 0,1 a 0,01 mg. Con vistas a poder pesar con fiabilidad también muestras con carga electrostática, Kern & Sohn ha incorporado en el dorso de la balanza un ionizador. Este dispositivo neutraliza la muestra con solo pulsar un botón.
Para laboratorios y la industria farmacéutica
La Kern ABP-A es ideal para las más diversas aplicaciones de laboratorio, como por ejemplo en la industria farmacéutica y en los laboratorios de investigación y de comprobación de la calidad. La tecla de tara/imprimir y la cruz de navegación facilitan, por ejemplo, el pesaje de fórmulas. Con ella, los componentes de la mezcla de la fórmula se numeran automáticamente y se imprimen con el número y el valor de peso.

La comunicación con los dispositivos externos, como un portátil, ordenador o sistemas LIMS, se realiza a través de un puerto RS-232 y una interfaz de datos USB para transmitir los datos de pesaje. Además, la balanza tiene un host USB para conectar un teclado USB, un escáner o un lápiz USB.
Acerca de Kern
Kern & Sohn GmbH, con sede en Balingen, en Baden-Württemberg, es sinónimo de alta precisión y fiabilidad y tiene una amplia gama de balanzas, microscopios y dispositivos de medición. Gottlieb Kern, fundador de la empresa, creó en 1844 en Baden-Württemberg las balanzas más precisas de su tiempo. También en la actualidad, en nuestra época de interconexión digital, Kern siempre se mantiene a la vanguardia tecnológica. Un almacén vertical totalmente automático se encarga de un rápido envío de los productos. Las pesas de control, los servicios de comprobación y el software completan nuestra cartera de productos y convierten a Kern en un proveedor integral y potente de tecnología de pesaje y medición.
www.kern-sohn.com
(Véase anuncio en la sección Guía del Comprador.)
Las tres compuertas correderas automáticas contribuyen a acelerar el proceso de pesaje de la balanza
técnicas de LABORATORIO 515 Nº 484 SEPTIEMBRE 2023 pesaje
Figura 2:
Reciclaje de catalizadores de vehículos
El convertidor catalítico del vehículo, también conocido como convertidor catalítico para abreviar, se utiliza para el postratamiento de gases de escape en vehículos con motores de combustión interna. El convertidor catalítico puede reducir drásticamente las emisiones contaminantes en los gases de escape.
La tarea del convertidor catalítico del vehículo es la conversión química de los contaminantes de la combustión: hidrocarburos (CmHn), monóxido de carbono (CO) y óxidos de nitrógeno (NOx) en las sustancias no tóxicas dióxido de carbono (CO2), agua (H2O) y nitrógeno (N2); así, los hidrocarburos (CmHn) y el monóxido de carbono (CO) se oxidan a dióxido de carbono (CO2) y agua (H2O), mientras que los óxidos de nitrógeno (NOx) se reducen a nitrógeno (N2). Dependiendo del punto de funcionamiento del motor, y en condiciones óptimas de
funcionamiento del catalizador se pueden lograr tasas de conversión cercanas al 100% con condiciones de operación óptimas del convertidor catalítico.
El convertidor catalítico del vehículo suele constar de varios componentes. Un cuerpo de panal de cerámica de temperatura estable, generalmente cordierita, que tiene una gran cantidad de canales de paredes delgadas, sirve como soporte. En el soporte se encuentra el llamado washcoat. Está hecho de óxido de aluminio poroso (Al2O3) y sirve para

incrementar la superficie. Debido a la alta rugosidad, se logra una superficie de hasta varios cientos de metros cuadrados por gramo. Las sustancias catalíticamente activas están incrustadas en el washcoat. Dependiendo del tipo de catalizador son diferentes. En el caso de los catalizadores modernos de tres vías, estos son, por ejemplo, los metales preciosos platino, rodio o paladio o bien una combinación de estos[1]. En las pruebas de laboratorio, el panel de cerámica se tritura hasta convertirlo en polvo, que luego se somete a pruebas para detec-

técnicas de LABORATORIO 516 Nº 484 SEPTIEMBRE 2023 preparación de muestras
Dagmar Klein, Sales Manager, Fritsch (info@fritsch.de)
Piezas cerámicas del catalizador con lateral de vellón
Cámara de molienda P19 Large después de la trituración
tar los metales preciosos catalíticamente activos.
Primer experimento
En el primer experimento, el cuerpo alveolar se trituró previamente en el molino de corte Pulverisette 19 Large. El equipo estaba provisto del rotor de la fresa de disco con insertos intercambiables y contracuchillas de carburo de tungsteno de metal duro WC+CO, un casete de tamiz de agujero cuadrado de 4 mm, así como un ciclón de alto rendimiento fabricado con acero inoxidable. El tiempo de trituración de la muestra fue de aproxidamente un minuto a una velocidad de 1.500 rpm.



Segundo experimento
En el experimento, parte de la muestra previamente triturada del Pulverisette 19 Large, se procesó posteriormente en el Pulverisette 14 premium line. Se trituraron 200 ml de la muestra hasta una
finura final de < 500 µm en 38 s. El Pulverisette 14 premium line estaba equipado con el rotor de corte y también conectado al ciclón de pequeño volumen, que se operaba de forma pasiva.
En principio, cuando se utiliza el molino de rotor de alta velocidad Pulverisette 14 premium line, es posible lograr una finura final máxima del material molido < 80 µm.
Tercer experimento
En el tercer experimento, parte de la muestra pretriturada del Pulverisette 19 Large se trituró aún más en el molino planetario Pulverisette 5 premium line El tiempo de molienda fue de un minuto, el equipo se hizo funcionar con vasos de molienda de óxido de circonio (ZrO2) de 125 ml y bolas de molienda de ZrO2 de 20 mm. La velocidad de rotación del disco solar se estableció en 450 rpm, la finura final lograda fue < 100 µm.

El Pulverisette 5 premium line tiene la ventaja de ser un sistema cerrado que impide la inhalación de sustancias nocivas durante el proceso de trituración. Además, el equipo ofrece la posibilidad de lograr una finura final de las muestras hasta el rango nano.
Conclusión
Con las pruebas realizadas, Fritsch pudo demostrar que tiene varias soluciones en cartera para triturar catalizadores. En un análisis más detallado, el usuario puede determinar cuán alta es, por ejemplo, la proporción de metales preciosos en el material triturado para decidir si existe algún potencial para recuperar los metales preciosos.
Referencias
[1]: Wikipedia Fahrzeugkatalysator.
www.fritsch.es
técnicas de LABORATORIO 517 Nº 484 SEPTIEMBRE 2023
de muestras
preparación
Descarga de la muestra en el recipiente de vidrio ciclónico
Descarga de muestra Pulverisette 14 premium line
Pulverisette 5 premium line con accesorios ZrO2
Pulverisette 14 premium line con ciclón de pequeño volumen
Recuento de hongos (levaduras y mohos) en el laboratorio cosmético:
método rápido Rapid YM Agar
frente a método clásico Sabouraud (resumen)
1. Objetivos
Comprobar si el método de recuento de hongos (levaduras y mohos) propuesto con Rapid YM Agar de Microkit (Ref. deshidratado DMT243, placas preparadas ECOPRYM, DryPlates DPPRYM) iguala o mejora la rapidez de obtención de resultados respecto al método estándar empleado hasta ahora en la mayoría de los laboratorios de análisis microbiológicos de productos cosméticos (Sabouraud SDA con Caf y con o sin gentamicina), y verificar si los detecta y enumera adecuadamente en las muestras procesadas. Es decir, comprobar que la técnica propuesta frente a la utilizada, los medios de cultivo utilizados y los analistas que intervienen en el control rutinario de recuento de hongos son idóneos, con resultados aptos y fiables, determinados mediante la exactitud y la precisión de nuestro método en los rangos de trabajo habituales.
Si el medio Rapid YM Agar a 35 °C es 2-3 días más rápido que el SDA clásico a 25 °C (5 días), con recuentos significativamente similares y como, además, en la anterior validación del recuento de aerobios, el medio propuesto PCA/TSA cromogénico también fue más rápido (2-3 días) que el estándar (TSA) a 2 y 5 días con recuentos significativamente similares, entonces podremos ahorrar tiempo en la liberación de nuestros lotes, ya que los demás parámetros (patógenos) tardan entre 3 y 4 días.
El parámetro objeto de la presente validación es el recuento de hongos (levaduras y mohos) reduciendo, gracias al Rapid YM Agar de Microkit, el tiempo de incubación de 5 días a solo 2-3 días (36-72 horas). Los hongos saprófitos que crecen a 25 °C son el indicador de la microbiota alterativa cuando el producto se va a almacenar a temperatura ambiente (primavera-otoño en países templados como España, incluso verano en países de latitudes altas). En cambio, los hongos patógenos y saprófitos que crecen a 35 °C (en verano) son un indicador de la microbiota asociada al hombre, pero en este medio la mayoría de los hongos que crecen a 25 °C también crecen a 35 °C (igual que los hongos fuera de medios de cultivo también crecen en verano), lo cual amplia el rango de especies
fúngicas alterativas, lo que permite que los recuentos, además de más rápidos, sean más altos y, por ello, más cercanos a la realidad.
2. Logística
El experimento se diseña con 30 muestras de diferentes cosméticos, inoculadas con diferentes combinaciones de microorganismos, triplicando en los tres rangos de recuento en placa (bajo, medio y alto): tres cepas de hongos (un moho: Aspergillus niger brasiliensis WDCM00053 y dos levaduras: Candida albicans WDCM00054 y la salvaje Rhodotorula mucilaginosa MKTM-R001). Se añaden dos bacterias interferentes, que a menudo hacen sinergia para hacerse resistentes al cloranfenicol: Pseudomonas aeruginosa WDCM00025 y la salvaje Staphylococcus hominis PECJJT.

El procedimiento es el método de pares, empleando por cada muestra dos placas de Sabouraud y dos de Rapid YM Agar, de modo que se comparan 360 placas (90x2 de Sabouraud y 90x2 de Rapid YM).
La concentración teórica de los distintos microorganismos inoculados en las muestras se recoge en la Tabla 1.
técnicas de LABORATORIO 518 Nº 484 SEPTIEMBRE 2023 validación cuantitativa
Laboratorios Microkit
A. niger sin la confluencia del Sabouraud + Rhodotorula 36 horas
validación cuantitativa
- Por cada muestra realizamos cuatro ensayos: dos en SDA por siembra en superficie de 0,2 mL y extensión con asa Digralsky y otros dos en Rapid YM Agar también por siembra en superficie de 0,2 mL y extensión con asa Digralsky. Ambos medios se incuban (introduciéndolas a la vez en cada estufa) a 20-25 °C durante 5 días para el Sabouraud, y a 30-35 °C
3. Resultados
durante 2 y 3 días para el Rapid YM Agar.
- Transcurrido el tiempo de incubación se hace el recuento de las colonias en cada una de las placas de cultivo. Se estudian los blancos de muestras sin cepas y los negros de cepas sin muestra para confirmar que no haya datos aberrantes a causa de las muestras o de las cepas.
técnicas de LABORATORIO 519 Nº 484 SEPTIEMBRE 2023
Tabla 1 Rango Aspergillus niger Candida Rhodototula Pseudomonas Staphylococcus albicans mucilaginosa aeruginosa hominis Bajo 1-9 1-9 1-9 <15 <15 Medio 10-18 10-18 10-18 20-50 20-50 Alto 18-90 18-90 18-90 70-200 68-200 Muestra Cepa Valor inóculo SDA Caf+G Rapid YM Agar Rapid YM Agar teórico 5 días 2 días 3 días 1 Aspergillus 1* 4,3 1,6 2,8 2 Candida 1* 9,12 9,6 9,9 3 Rhodotorula 1* 10,10 12,14 15,15 4 Aspergillus 2* 25,24 0,0 0,0 5 Candida 2* 1,2 18,18 19,22 6 Rhodotorula 2* 10,11 1,1 1,1 7 Aspergillus 3 13,10 13,10 13,10 8 Candida 3 1,3 3,4 3,5 9 Rhodotorula 3 3,3 2,3 2,3 10 Aspergillus 4 14,11 15,15 15,15 11 Candida 4 3,1 3,3 4,3 12 Rhodotorula 4 5,5 2,3 2,3 13 Aspergillus 5 18,18 14,19 16,21 14 Candida 5 4,5 7,6 8,6 15 Rhodotorula 5 3,4 6,7 7,10 16 Aspergillus 6 12,20 20,21 21,20 17 Candida 6 3,6 2,6 2,9 18 Rhodotorula 6 9,8 10,4 11,4 19 Aspergillus 7 22,15 20,19 19,20 20 Candida 7 8,3 7,10 7,10 21 Rhodotorula 7* 1,0 0,0 0,0 22 Aspergillus 8 30,28 28,23 29,26 23 Candida 8 5,16 6,8 6,8 24 Rhodotorula 8 11,16 9,16 9,17 25 Aspergillus 9 24,12 20,21 23,26 26 Candida 9 16,7 3,7 3,8 27 Rhodotorula 9 5,6 6,3 7,4 28 Pseudomonas (18) 0,0 0,0 0,0 29 Staphylococcus (15) 0,0 0,0 0,0 30 Pseud + Staph (33)* 168,200 96,106 146,116 ∑ ambas placas hongos 406 404 435 Comparativa total 99,51% del 107,14% más que el SDA (En rojo los resultados descartados SDA en 5 días, en 5 días y 107,67% más como aberrantes) prácticamente idéntico que Rapid YM en 2 días
Rango bajo (placas duplicadas de la dilución madre (-1)
3.1
validación cuantitativa
En este rango bajo, a igualdad de inóculos, el Rapid YM Agar obtiene en solo dos días el 99,5% de las colonias que el SDA en 5 días. Y en solo 3 días, obtiene el 108% de las colonias que el SDA en cinco. De modo que ambos tiempos de incubación del Rapid YM son equivalentes al método clásico de 5 días en SDA, no hace falta esperar 5 días en el recuento de hongos con SDA, ni siquiera 3 días con Rapid YM, y con 2 días es suficiente, ya que en microbiología se acepta que recuperaciones superiores al 95% en los recuentos, equivalen al 100%, por lo que perfectamente ya lo podríamos sustituir sin necesidad de observar lo que ocurre en los rangos medio y alto, que son menos significativos en microbiología cosmética a causa de los máximos normativos.
En el rango medio (tabla inferior), a igualdad de inóculos, el Rapid YM Agar obtiene en solo 2 días más colonias (108%) que el SDA en 5. Casi un 10% más de colonias. Y en solo 3 días obtiene el 120% de las colonias que el SDA en 5 días, lo cual ya es una diferencia muy significativa (20% superior), de modo que ambos tiempos de
incubación del Rapid YM son equivalentes al método clásico de 5 días en SDA, no hace falta esperar 5 días en el recuento de hongos con SDA, ni siquiera 3 con Rapid YM, y con 2 días es suficiente.
En el rango alto (tabla de la página siguiente), a igualdad de inóculos, el Rapid YM Agar obtiene en solo 2 días más colonias (136%) que el SDA en 5. ¡Un 36% más de colonias! Y en solo 3 días, obtiene el 149% de las colonias que el SDA en 5 días, lo cual ya es una diferencia muy significativa (49% superior), de modo que ambos tiempos de incubación del Rapid YM son equivalentes al método clásico de 5 días en SDA, no hace falta esperar 5 días en el recuento de hongos con SDA, ni siquiera 3 con Rapid YM, y con 2 días es suficiente.
Nota: Curiosa demostración de la sinergia entre una bacteria gram positiva y una gram negativa para, juntas, combatir la presencia de cloranfenicol y hacerse viables, cuando, por separado, queda claro que no crecen en estos medios con CAF y las muestras donde las inoculamos por separado sirven de blancos sin hongos.
técnicas de LABORATORIO 520 Nº 484 SEPTIEMBRE 2023
Muestra Cepa Valor inóculo SDA Caf+G Rapid YM Agar Rapid YM Agar teórico 5 días 2 días 3 días 31 Aspergillus 10 24,20 17,30 23,32 32 Candida 10 8,8 4,12 5,12 33 Rhodotorula 10 8,12 9,9 10,9 34 Pseudomonas (38) 0,0 1,1 1,1 35 Staphylococcus (30) 0,0 1,1 1,1 36 Pseud + Staph (68) 0,0 1,1 1,1 37 Aspergillus 11 30,25 36,30 38,40 38 Candida 11 4,9 7,4 10,4 39 Rhodotorula 11 16,13 1,11 12,12 40 Aspergillus 12 31,23 27,34 32,35 41 Candida 12 12,6 13,6 13,6 42 Rhodotorula 12 13,13 13,17 13,19 43 Aspergillus 13 25,24 24,27 26,33 44 Candida 13 8,16 6,13 6,13 45 Rhodotorula 13 11,18 13,13 13,13 46 Aspergillus 14 32,30 35,28 37,28 47 Candida 14 7,10 10,10 11,10 48 Rhodotorula 14 13,19 17,16 19,16 49 Aspergillus 15 28,27 35,38 40,44 50 Candida 15 16,10 15,18 15,18 51 Rhodotorula 15* 3,1 0,0 0,0 52 Aspergillus 16 30,37 27,45 34,53 53 Candida 16 15,11 21,14 24,16 54 Rhodotorula 16 32,22 30,23 35,26 55 Aspergillus 17 30,36 45,37 46,41 56 Candida 17 15,18 11,15 13,16 57 Rhodotorula 17 14,13 7,10 7,12 58 Aspergillus 18 19,14 36,28 37,30 59 Candida 18 21,19 22,23 23,17 60 Rhodotorula 18* 292,240 384,432 393,460 ∑ ambas placas hongos 915 992 1.097 Comparativa total 108,42% por encima 119,89% más que el (En rojo los resultados descartados del SDA en 5 días SDA en 5 días y 110,58% como aberrantes) más que Rapid YM en 2 días
3.2 Rango medio (placas duplicadas de la dilución madre (-1)
4. Estudio estadístico de los datos
La exactitud medida como recuperación relativa media en % respecto a cepas cuantitativas certificadas (como criterio estándar, ver ejemplos de fertilidad mínima para medios generales y selectivos en los anexos de la Norma ISO 11133-2: 50-95%) no nos interesa en esta validación. Lo que queremos comprobar es la exactitud (y además la rapidez) del medio Rapid YM Agar de Microkit con respecto al SDA estándar.

técnicas de LABORATORIO 521 Nº 484 SEPTIEMBRE 2023
validación cuantitativa
3.3 Rango alto (placas duplicadas de la dilución madre (-1)
Muestra
inóculo SDA Caf+G Rapid YM Agar Rapid YM Agar teórico 5 días 2 días 3 días 61 Aspergillus 20 17,20 49, 55 49,55 62 Candida 20 17,12 8,19 9,22 63 Rhodotorula 20 5,14 26,29 27,29 64 Aspergillus 22* 0,0 0,0 0,0 65 Candida 22 6,15 9,14 9,15 66 Rhodotorula 22 23, 18 18,17 18,17 67 Aspergillus 24 32,29 49,42 49,43 68 Candida 24 21,16 16,23 18,26 69 Rhodotorula 24 24,37 20,17 20,20 70 Aspergillus 26 34,38 41,54 44,64 71 Candida 26 21,13 23,21 27,24 72 Rhodotorula 26 28,22 29,14 31,18 73 Aspergillus 28 46,38 55,61 55,64 74 Candida 28 12,24 14,16 16,23 75 Rhodotorula 28 21,24 20,18 28,18 76 Pseudomonas (54) 0,0 0,0 0,0 77 Staphylococcus (45) 0,0 0,0 0,0 78 Pseud + Staph (99) 0,0 0,0 0,0 79 Aspergillus 30 42,40 72,76 80,76 80 Candida 30 32,22 23,21 26,24 81 Rhodotorula 30* 1,1 0,0 0,0 82 Aspergillus 40 37,44 88,74 88,74 83 Candida 40 15,21 21,25 31,36 84 Rhodotorula 40 62,48 44,56 63,60 85 Aspergillus 50 34,38 46,98 46,103 86 Candida 50 30,27 26,36 36,36 87 Rhodotorula 50 17,22 36,13 36,18 88 Aspergillus 90 42,46 94,90 94,102 89 Candida 90 32,63 50,60 50,76 90 Rhodotorula 90* Incontables Incontables Incontables (masa asalmonada) (masa asalmonada) (masa asalmonada) ∑ ambas placas hongos 1.341 1.826 2.003 Comparativa total 136,17 % por encima 149,37% más que el SDA (En rojo los resultados descartados del SDA en 5 días en 5 días y 109,69% más como aberrantes) que Rapid YM en 2 días
Candida albicans con halos en 3 días
Cepa Valor
validación cuantitativa
Exactitud absoluta entre el Rapid YM Agar 2 dias a 35 °C y el SDA 5 días a 25 °C
Excelente, superior al 90% necesario según ISO 11133-2 e incluso >100% de excelencia en menos tiempo que el SDA (ahorra 3 días)
Exactitud absoluta entre el Rapid YM Agar 3 dias a 35 °C y el SDA 5 días a 25 °C
Excelente, superior al 90% necesario según ISO 11133-2 e incluso >100% de excelencia en menos tiempo que el SDA (ahorra 2 días)
Otras conclusiones interesantes: El Rapid YM Agar obtiene resultados muy similares cuando se incuba a 35ºC en 2 y en 3 días (48 h y 72 h)
De modo que podemos reducir el tiempo de incubación de Hongos, incluyendo los alterativos en verano y asociados al hombre, (saprófitos a 35ºC), de 5 días a sólo
La conclusión es clara: podemos trabajar con plena confianza con Rapid YM Agar y ahorrar 2 o incluso, si nos conviene (leer las placas de recuento de aerobios y de hongos el mismo día), 3 días de incubación. Por tanto, el recuento de hongos deja de ser uno de los dos hándicaps que nos obligaban hasta ahora a retener el producto final durante 5 días. Como ya resolvimos el otro hándicap, cuando validamos el PCA cromogénico para recuento total de aerobios en 48 horas (sean aerobios asociados al hombre o alterativos en verano, a 35 °C, sean aerobios alterativos en las temperaturas de almacenamiento de
primavera-otoño a 25 °C); la cuarentena de stock de producto terminado la pasan a marcar desde ahora los patógenos lentos (sobre todo Staphylococcus aureus, con sus 3-4 días entre enriquecimiento + aislamiento en placa).
Precisión: No era el motivo de esta validación centrarnos en este parámetro, que en este caso mide sobre todo el trabajo repetitivo del analista en los duplicados de placas, pero aun así estudiaremos los pares de cada placa. Los resultados de SDA a 5 días y de Rapid YM Agar a 2 días
técnicas de LABORATORIO 522 Nº 484 SEPTIEMBRE 2023
indican: Rango de medida Recuento en Rapid YM Agar Recuento en SDA Recuento 2 días 5 días Rapid YM Agar /SDA Bajo 404 colonias/60 placas 406 colonias/60 placas 99,51% Medio 992 colonias/60 placas 915 colonias/60 placas 108,42% Alto 1.826 colonias/60 placas 1.341 colonias/60 placas 136,17% Exactitud absoluta media 114,7% Rango de medida Recuento en Rapid YM Agar Recuento en SDA Recuento 3 días 5 días Rapid YM Agar /SDA Bajo 435 colonias/60 placas 406 colonias/60 placas 104,14% Medio 1.097 colonias/60 placas 915 colonias/60 placas 119,89% Alto 2.003 colonias/60 placas 1.341 colonias/60 placas 149,37% Exactitud absoluta media 124,47% Rango de medida Recuento en Rapid YM Agar Recuento en Rapid YM Aga Recuento 2/3 días 2 días 3 días Bajo 404 colonias/60 placas 435 colonias/60 placas 92,87% Medio 992 colonias/60 placas 1.097 colonias/60 placas 90,43% Alto 1.826 colonias/60 placas 2.003 colonias/60 placas 91,16% Exactitud absoluta media 91,49 % (>90%)
validación cuantitativa
En ambos casos los medidores de la precisión están dentro de los rangos más estrictos, sobre todo en el caso del Rapid YM Agar (por debajo de CV 25%)
En ambos casos los medidores de la precisión están dentro de los rangos más estrictos, por debajo de CV 25%. Como es habitual, el rango medio es el más preciso
En ambos casos los medidores de la precisión están dentro de los rangos más estrictos, por debajo de CV 25%
La precisión resulta bastante similar en ambos medios, ya que es una variable que depende más del analista que del medio.
La linealidad es el grado de concordancia entre lo esperable (ufc/inóculo) y lo detectado (colonias/placa) en los diferentes rangos de recuento en placa:
técnicas de LABORATORIO 523 Nº 484 SEPTIEMBRE 2023
Rango SDA 5 días Rapid YM Agar 2 días alto Muestra Datos, Media Sm CV% Datos, Media Sm CV% Sm/Media Sm/Media Total 1.341 - 22,29% 1,826 - 19,3% Rango SDA 5 días Rapid YM Agar 2 días medio Muestra Datos, Media Sm CV% Datos, Media Sm CV% Sm/Media Sm/Media Total 915 - 19,11% 992 - 21,21% Rango SDA 5 días Rapid YM Agar 2 días bajo Muestra Datos, Media Sm CV% Datos, Media Sm CV% Sm/Media Sm/Media Total 406 - 31,65% 404 - 24,92% Nº ufcs inoculadas Recuento en placa del método a validar Linealidad Rango de medida Rtos. medios en SDA, 5 días Rtos. medios en Rapid YM Agar, y valor estimado medio 2 días Bajo: 5 ufc/inóculo 406/60 col/placa = 6,77 404/60 col/placa = 6,73 Medio: 14 ufc/inóculo 915/60 col/placa = 15,25 992/60 col/placa = 16,53 Alto: 37 ufc/inóculo 1.341 /60 col/placa = 22,35 1.826/60 col/placa = 30,43
validación cuantitativa
vidad es pues del 1-(6/180) x100 = 96,66%, superior al típico 90% y al estricto 95%.
La especificidad exclusiva (exclusividad) es la escasez de falsos positivos con diferentes interferentes. Falsos positivos de bacterias ha habido 5 de 18. En el rango bajo, Pseudomonas y Staphylococcus hicieron sinergia para combatir el cloranfenicol de las placas de ambos medios, lo que demuestra que, en la rutina del laboratorio, en cualquier medio con CAF, algunas colonias con aspecto de levadura podrían ser de bacterias. Al no haberlos mezclado con levaduras ni mohos, hemos podido detectarlos, pero ahora ya sabemos que algo así puede suceder. En las muestras naturales la exclusividad de ambos medios con cloranfenicol es muy probable que se acerque al 100%.
La linealidad ha quedado demostrada en ambos medios porque las medias obtenidas de los recuentos en placa van subiendo conforme suben los valores inóculo, en cada unos de los rangos, de una forma muy evidente, aún mejor en Rapid YM Agar que en SDA.
La selectividad inclusiva (inclusividad) es la escasez de falsos negativos con diferentes dianas.
Hay unos escasos falsos negativos, 100% achacables al poder inhibitorio de dos matrices (ya que se repiten en ambos medios y en los tres rangos para un hongo concreto, en un caso Aspergillus –matrices 4 y 64- y en otro Rhodotorula –matrices 21, 51 y 81). En el rango más bajo que se puede incluir en una validación no hay falsos negativos, por lo que ambos medios funcionan muy bien al respecto. Incluso en valores normalmente indetectables a causa de la incertidumbre (como son solo 1 o 2 ufc/inóculo), de modo que en el total de 180 muestras (30 x 3 rangos x 2 medios) hay 6 con falso negativo de estos dos microorganismos entre ambos medios, mientras Candida albicans no ha sufrido ningún caso de falsos negativos. La inclusi-
También se puede considerar un parámetro bastante robusto: no hay enormes diferencias en el recuento entre ambos medios. La diferencia entre ambos es el tiempo de incubación, muy inferior en el Rapid YM Agar (2 días) respecto el del SDA (5 días).
5.Conclusiones
Por todo ello, se considera validado el parámetro de recuento de hongos en nuestras muestras cosméticas, empleando Rapid YM Agar de Microkit frente al SDA, con mejores resultados: recuentos medios más elevados, más cercanos a la realidad; y recuentos fiables muchísimo más rápidos (2 días en vez de 5).
El objetivo de conveniencia de este laboratorio era validar este medio en 48 horas, pero sabemos que es todavía más rápido y detecta y enumera perfectamente desde las primeras 36 horas tanto las levaduras como los mohos (ver validación Rapid-YM en alimentos frente a SDA y a DRBC y fotografías de abajo).
www.microkit.es
(Véase anuncio en la sección Guía del Comprador.)
Candida y Aspergillus en solo 36 horas en Rapid YM Agar de Microkit



técnicas de LABORATORIO 524 Nº 484 SEPTIEMBRE 2023
Mix de levaduras y mohos en 36 horas
Noticias
SERVIQUIMIA
Soluciones integrales para el laboratorio y la industria
Serviquimia, empresa del grupo Calibre, es líder en soluciones para el laboratorio en España, con una extensa gama de productos, una red de distribución en toda la península y una trayectoria de más de 40 años en la industria. Su capacidad para satisfacer una amplia variedad de necesidades de los clientes y ofrecer servicios integrales para el laboratorio la ha convertido en una opción confiable para sus clientes.

Fundada en 1981, Serviquimia cuenta con venta directa en Cataluña y Madrid, y una red de distribución que abarca toda la península. La empresa atiende a clientes de numerosos sectores, desde empresas químicas, petroquímicas y agroalimentarias hasta universidades, centros de investigación y más. Como socios fundadores de LLG y con
importantes acuerdos de representación oficial con algunos de los fabricantes más destacados del sector (como Memmert, Huber, Merck, Avantor, ChemLab, SPEX, Reagecon y Aqualytic, entre otros), Serviquimia ofrece una cartera de productos amplia e innovadora que permite a sus clientes satisfacer una gran variedad de necesidades.
Serviquimia se posiciona también como una de las pocas empresas en España capaz de diseñar, montar, amueblar y equipar un laboratorio desde cero. La compañía también ofrece una gama completa de posibilidades para el laboratorio que incluyen servicios de preventa y posventa, mantenimiento, reparaciones y consultoría y cuenta con un equipo comercial, de compras y logística muy cualificado para ofrecer el mejor
servicio de atención y asesoramiento a sus clientes.
Serviquimia anuncia su participación junto con Glass Chemicals, empresa del mismo grupo madre, en la IX edición de Farmaforum, foro de la Industria farmacéutica, biofarmacéutica y tecnologías de Laboratorio que se celebrará el 20 y 21 de septiembre en las instalaciones de IFEMA en Madrid. Los visitantes tendrán la oportunidad de conocer de cerca la amplia gama de productos y servicios que ofrece la empresa. Para obtener más información, visite su web o llame al +34 977 524 477.
www.serviquimia.com
(Véase anuncio en la sección Guía del Comprador.)
técnicas de LABORATORIO 525 Nº 484 SEPTIEMBRE 2023 noticias
CARBUROS METÁLICOS Incorporación a la Plataforma Tecnológica Española del CO2
Carburos Metálicos, compañía del sector de gases industriales y medicinales en España y que forma parte del grupo Air Products, formalizó su adhesión a la Plataforma Tecnológica Española del CO2 (PTECO2), convirtiéndose así en socio de pleno derecho de dicha entidad y ampliando su compromiso con los objetivos europeos de descarbonización fijados para 2050.

La Plataforma, que cuenta con el aval de la Agencia Estatal de Investigación (Ministerio de Ciencia e Innovación) y sus más de 50 miembros, trabaja desde 2006 para impulsar en España las tecnologías de captura, almacenado, usos y transformación del CO2, denominadas también como CAUC y CCUS por sus siglas en inglés.
La adhesión de Carburos Metálicos tuvo lugar durante la 43ª reunión del Consejo Rector de PTECO2. Con anterioridad a dicha reunión, se había celebrado un encuentro informal entre el director General de Carburos Metálicos y vicepresidente Sur de Europa y el Magreb de Air Products, Miquel Lope, y el presidente de la PTECO2, Pedro Mora Peris, en la sede de PTECO2, para analizar y debatir sobre los objetivos a alcanzar durante los próximos años en materia de descarbonización.
En este encuentro, ambos coincidieron en la idea fundamental de que “las tecnologías CAUC deben llegar al mercado lo antes posible mediante la promoción de grandes proyectos de captura, almacenamiento y usos del CO2 en nuestro país, que dispone de un gran conocimiento y potencial para lograrlo”. En este encuentro, los representantes de Carburos Metálicos y PTECO2 estuvieron acompañados por la directora de Relaciones Institucionales y Asuntos Regulatorios sur de Europa en Air Products, Esperanza Montero, y el director de Desarrollo de Negocio de Air Products, Daniel Lorenzetto.
El paso dado por Carburos Metálicos está alineado con su objetivo de soste-
nibilidad ‘Third by ‘30’ que contempla reducir un tercio de la intensidad de sus emisiones de CO2 directas, indirectas y las que provienen de la cadena de valor de aquí a 2030, como paso previo para alcanzar la neutralidad en carbono de sus operaciones en 2050. Dos de las actuales líneas estratégicas de la compañía son el impulso a la captura de CO2 y el hidrógeno para movilidad y la descarbonización de la industria. Actualmente, Carburos Metálicos cuenta con dos plantas de captura y reutilización de CO2 en Telde (Gran Canaria) y Garray (Soria) que han recibido diversos reconocimientos por su carácter pionero en España. Asimismo, la compañía forma parte del mayor productor mundial de H2, el Grupo Air Products, que ha participado en más de 250 proyectos de estaciones de servicio de H2 en una veintena de países desde
1993. También dispone de la mayor red mundial de distribución canalizada de H2 y una amplia cartera de patentes relacionadas con su repostaje, por lo que está presente en toda su cadena de valor. En la actualidad, las tecnologías de repostaje de Air Products proporcionan más de 1,5 millones de recargas de H2 al año.
“Tenemos un enfoque colaborativo respecto a la transición energética y por eso estamos muy satisfechos de sellar nuestra adhesión a la Plataforma Tecnológica Española del CO 2. Apoyándonos en nuestra experiencia en las últimas tecnologías de captura de CO 2, confiamos en aportar un impulso significativo a la labor que la PTECO2 realiza para reducir progresivamente la huella de carbono de las actividades humanas en nuestro país”, comentó Lope.
técnicas de LABORATORIO 526 Nº 484 SEPTIEMBRE 2023
noticias
De izquierda a derecha, Pedro Mora Peris, Esperanza Montero, Daniel Lorenzetto y Miquel Lope
INTEGRA
Gane un dispensador de reactivos Welljet para revolucionar sus capacidades de manejo de líquidos

Integra Biosciences ofrece la oportunidad de ganar un dispensador de reactivos Welljet, junto con todos los accesorios necesarios para llevar la dispensación a granel a otro nivel.
El Welljet es un innovador dispensador de reactivos rápido, flexible y preciso que ayuda a eliminar la repetitiva tarea de llenar manualmente las placas de pocillos, facilitando la dispensación a granel de reactivos y haciéndola más eficiente que nunca. El sistema minimiza la variabilidad de canal a canal y garantiza la consistencia de las tareas de manejo de líquidos, gracias a sus revolucionarios casetes de dispensación EasySnap™, que pueden insertarse y extraerse fácilmente sin requerir una recalibración. Además, este instrumento es el más pequeño y compacto de su clase en el mercado, lo que hace que sea un fichaje ideal para cualquier laboratorio.
El premio incluye:
- Una unidad base dispensadora de reactivos Welljet (sin apilador)
- Una caja de casetes de 8 canales de calibre pequeño
- Una caja de casetes de 8 canales de calibre grande
- Un soporte para tubos.
DISTINCIONES
¡Mejore su capacidad de dispensación en un abrir y cerrar de ojos! Solo tiene que completar el cuestionario que hallará en la web de Integra para tener la oportunidad de ganar su dispensador de reactivos Welljet. No se demore: la fecha límite para participar es el 30 de septiembre de 2023. ¡Buena suerte!
www.integra-biosciences.com
Miguel Rovira, galardonado en los II Premios CEO del Año de La Razón
Miguel Rovira, director General de ACO Iberia & Sudamérica, recibió el 14 de junio en Madrid el premio CEO del Año que otorga el periódico La Razón por su trayectoria y liderazgo en soluciones tecnológicas avanzadas para el tratamiento y la gestión del agua. Estos premios, cuyo objetivo es reconocer la labor de las personas que lideran y gestionan las empresas, se entregaron a 38 profesionales de diferentes compañías y sectores referentes en España.

Al recibir el premio, Rovira quiso trasladar con sus palabras de agradecimiento el sentimiento de que la fuerza de todo el equipo humano de ACO es determinante a la hora de lograr este tipo de reconocimientos. Por ello, remarcó que “para mí y para mi equipo, este galardón representa un gran reconocimiento al trabajo bien hecho, pero también a la apuesta que hicimos para buscar una nueva visión de la cultura empresarial, que es lo que nos permite mejorar cada día”.
Miguel Rovira en la gala de entrega de los II Premios CEO del Año de La Razón (foto: La Razón)
Hace 24 años, Miguel Rovira entró a formar parte del Grupo ACO como técnico comercial en la zona centro de Portugal. Ingeniero civil de formación, es hoy en día el máximo responsable de estrategia de ACO Iberia & Sudamérica. Uno de sus objetivos actuales es convertir a ACO en un referente del sector de la reutilización del agua. Desde su punto de vista, es un campo nuevo en lo referente a la gestión de los recursos hídricos, “lo que te obliga a ser aún más atrevido y valiente”. La ceremonia de entrega de los II Premios CEO del año tuvo lugar en la sede de La Razón en Madrid y abarcó gran parte de la jornada. La gala la presentó la periodista Marina Castaño, y contó con la presencia de Eugenia Carballedo, hasta la víspera presidenta de la Asamblea de Madrid, y Andrés Navarro, consejero delegado de La Razón. Francisco Marhuenda, director del diario, aprovechó la ocasión para señalar que los galardones que allí se repartían servían para reconocer la labor de “las personas que saben gestionar a personas”.
técnicas de LABORATORIO 527 Nº 484 SEPTIEMBRE 2023
noticias
noticias
AVANCE
XXI Workshop sobre métodos rápidos y automatización en microbiología alimentaria -memorial DYCFung-

- Fecha y lugar: 21-24 de noviembre de 2023; Facultad de Veterinaria de la Universitat Autònoma de Barcelona (UAB; Bellaterra, Cerdanyola del Vallès).
- Objetivo: ampliar y difundir los conocimientos teóricos y prácticos sobre métodos innovadores para detectar, contar, aislar y caracterizar rápidamente los microorganismos, y sus metabolitos, habituales en los alimentos y el agua.
- Colectivos destinatarios: directores y técnicos de industrias consultorías y laboratorios agroalimentarios, y de otros sectores (microbiológico, biotecnológico, clínico, farmacéutico, cosmético, químico, ambiental, etc.); inspectores y demás personal de la administración; estudiantes de grado y posgrado, personal técnico y profesores universitarios; personal de otros centros de investigación; etc.
- Ponentes y ponencias:
• Dr. José Juan Rodríguez Jerez (UAB): Visión general de los métodos rápidos y miniaturizados, y la automatización en microbiología
• Dr. Armand Sánchez Bonastre (UAB): La polymerase chain reaction (PCR) y la secuenciación genómica masiva aplicadas a la seguridad alimentaria
• Dra. Anna Pinar Méndez (Aigües de Barcelona, Barcelona): Más allá de la legislación: comparación entre métodos de cultivo y moleculares para evaluar la calidad del agua potable
• Sara García-Gurtubay (Compliance &Values, Leioa): ¿Quiénes, cuándo y por qué deben responder legalmente en las industrias alimentarias?
• La cultura de la inocuidad alimentaria: ¿son nuestros alimentos más seguros que nunca?:
o Pascal Monzó Martos (Productos Florida, Vila-real)
o Dr. Oscar J. Esteban Cabornero
(Grupo Entrepinares Valladolid)
o Jon Basagoiti Azpitarte (Imagining Management Systems, Ermua)
o David Tomás Fornés (GT Normalización de métodos microbiológicos ISO/CEN, Valencia)
• Dra. Nathalie Gnanou Besse (ANSES, Maisons-Alfort, Francia): Listeria monocytogenes: novedades en la normativa e impacto de la diversidad genética sobre su comportamiento y detección
• Dra. Marta Hugas Maurici (experta independiente, exdirectora científica EFSA, Girona): Tendencias de futuro en seguridad alimentaria
- Talleres:
• Adaptación a los últimos cambios en FSSC22000 v6, IFS Food v8 y BRCGS FS v9 (sin morir en el intento)
• Prevención del desperdicio alimentario: requerimientos legales y estrategias de mitigación
• ¿Peligros microbiológicos en los sistemas APPCC? ¡Por fin, identifícalos correctamente en tu empresa!
• Uso de los recursos para microbiología predictiva disponibles en internet
Y también:
* Sesiones prácticas en laboratorio durante tres días.
* Exhibiciones a cargo de 13 empresas de microbiología (se explica y muestra el funcionamiento de equipos y productos).
* Mesas redondas: ¿Son nuestros alimentos más seguros que nunca? / Instrumentación, tendencias del mercado mundial, otros temas de actualidad.
- Precios: Sesiones prácticas: 90 EUR. Resto del workshop: 230 EUR (o 130 EUR/1 día); estudiantes UAB: 35 EUR; personal UAB: 110 EUR; estudiantes no UAB: 140 EUR (o 80 EUR/1 día).
Descuentos: 15% para suscriptores de las revistas eurocarne, Técnicas de Laboratorio o Tecnifood; 50% para cuatro socios -con antigüedad superior a tres años- de la Associació Catalana de Ciències de l’Alimentació (ACCA); 15% para socios de la Associació Catalana de Científics i Tecnòlegs dels Aliments.
Información actualizada y detallada:
https://webs.uab.cat/workshopmrama
técnicas de LABORATORIO 528 Nº 484 SEPTIEMBRE 2023
DEKRA
Acreditación como laboratorio de ensayo de aerogeneradores
Dekra se posiciona como una de las cinco empresas acreditadas en España en este ámbito. Completa así un porfolio de servicios completo y diferencial: instalación de torres y LiDARS, certificación del montaje, cálculo de prueba de potencia y seguimiento del recurso eólico.
La Entidad Nacional de Acreditación (ENAC) ha concedido a Deka la acreditación como “Laboratorio de Ensayo ISO 17025 para medir la Curva de Potencia de Aerogeneradores, Calibración de Emplazamiento, Evaluación del terreno en el área de ensayo y Toma de datos eólicos para evaluación del potencial eólico” según norma IEC 61400-12-1:2017, documentos de MEASNET y método interno PE-SGI-ER-11 de Dekra basado en la misma norma.
La acreditación de ENAC es una herramienta que permite a los laboratorios demostrar, entre otros aspectos, que disponen de los recursos materiales y humanos necesarios, que ejecutan de forma correcta sus ensayos empleando métodos técnicamente válidos y controlados y que esos ensayos están sometidos a estrictos controles internos y externos para asegurar la validez de sus resultados. Implica un proceso de evaluación y mejora continua de los métodos y procedimientos utilizados para la evaluación del recurso eólico. Esto asegura que el laboratorio esté actualizado con las mejores prácticas y tecnologías disponibles, para ofrecer servicios de alta calidad.
La curva de potencia es un concepto clave para comprender la eficiencia de los aerogeneradores. Los fabricantes están obligados a asociar una curva de potencia a cada modelo de aerogenerador para una densidad de aire estándar (1,225 kg/m3) u otras densidades inferiores. Sin embargo, los emplazamientos donde se instala un aerogenerador pueden ser muy diversos, por lo que puede que el aerogenerador en cierto emplazamiento no se comporte de la misma manera que en las condiciones de referencia. Por ello, se realizan ensayos de prueba de potencia.
La acreditación de laboratorio de ensayo es fundamental para: - Verificación del rendimiento de aerogeneradores: verificar que cumplen con las especificaciones y garantías dadas por el fabricante.
- Reducción de la incertidumbre de la producción del prevista relativa al aerogenerador ensayado: el cliente obtiene más certidumbre en la estimación de ingresos.
Se trata de un análisis que puede ser realizado por los laboratorios acreditados por las entidades de acreditación de cada país, en el caso de España el cuerpo de acreditación es ENAC, donde se certifica la potencia eléctrica real que genera la turbina a diferentes velocidades de viento en un cierto emplazamiento. El resultado de este ensayo debe compararse con la curva de potencia estándar del aerogenerador.
Antes de explotar un parque eólico es recomendable realizar un ensayo sobre un aerogenerador ubicado en el emplazamiento, de forma que se certifique que dicha máquina cumple
con las especificaciones del fabricante en lo que a la producción de energía eléctrica se refiere.
Esta acreditación premia la experiencia de muchos años en medición de recurso. La acreditación obtenida para ser laboratorio de ensayo según ISO 17025 es solo el primer paso. El objetivo de Dekra es su incorporación a la red de laboratorios MEASNET (The Internacional Measuring Network of Wind Energy), prestigiosa organización internacional garantía de calidad en las medidas de curva de potencia, calidad de energía, emisión de ruido y calibración de anemómetros. Y además incorporarse a IECRE.
“La certificación como Laboratorio de Ensayos de Curva de Potencia es una consecuencia del buen trabajo que Dekra realiza desde hace años para asegurar la calidad y la seguridad de los sistemas y demuestra la competencia técnica”, destaca Josep Dalfó, director de Dekra Industrial Spain.
Dekra Green Energies acompaña a sus clientes a lo largo de la vida del proyecto renovable con un amplio abanico de servicios técnicos y asesoría. Gracias a este hito Dekra puede ofrecer un servicio completo y diferencial: instalación del mástil, certificación del montaje, cálculo de prueba de potencia y seguimiento del recurso eólico. Además, permite ofertar ensayos de toma de datos eólicos con mayor bancabilidad (susceptibilidad de un proyecto de ser financiable).

Dekra es uno de los principales actores a escala mundial en medición del recurso eólico, con un servicio exportable a cualquier mercado internacional: a través de un sistema de acuerdos internacionales, los resultados obtenidos por un laboratorio acreditado de un determinado país tienen reconocimiento en otros países (ILAC).
En el área Industrial, paraguas bajo el que se encuentra el Departamento de Green Energies, se ofrecen los servicios de: Energías renovables, seguridad y consultoría medioambiental, Sostenibilidad y transición energética, Control ambiental, seguridad y salud laboral, Seguridad contra incendios, Formación, Control de actividades, Seguridad industrial y Control de edificación.
técnicas de LABORATORIO 529 Nº 484 SEPTIEMBRE 2023
noticias
COSMETORIUM
Avance del programa científico
Los días 18 y 19 de octubre tendrá lugar en el Palau de Congressos de Barcelona (Montjuïc) Cosmetorium. Ideado por la SEQC (Sociedad Española de Químicos Cosméticos) y organizado por dicha sociedad y Step Exhibitions, es un encuentro sobre creación, formulación, desarrollo, suministro, fabricación y subcontratación de productos cosméticos.

La inteligencia artificial y sensorial, la innovación en sostenibilidad o la certificación de productos cosméticos serán los temas influyentes que los expertos invitados de este año articularán a lo largo de las nueve conferencias que conformarán el programa científico de los dos días de la cita.
18 de octubre
10:00 - 11:00
El camino del miedo al éxito
Julio de la Iglesia, Gestión del Miedo
11:15 - 11:45
Descubrimientos impulsados por la IA en el espacio proteínico y molecular para la cosmética avanzada
Alexis Molina, director de Inteligencia Artificial, Nostrum
11:45 - 12:15
Inteligencia artificial generativa en la personalización de la belleza y el cuidado de la piel: oportunidades y retos
Dr. Albert Fornells, jefe del departamento de métodos cuantitativos IQS, Universidad Ramon Llull
12:30 - 13:00
Cómo innovar en envases sostenibles para aplicaciones cosméticas sin dejar de tener un envase seguro
Dra. Soraya Sanchez, jefe de proyectos del Área de Nuevos Materiales y Envases, ITENE; Dra. Miriam Gallur, gerente del Área de Nuevos Materiales y Envases, ITENE
13:00 - 13:30
Del residuo al valor: bioplásticos
Noelia Márquez, CEO y Co-founder, Venvirotech.
19 de octubre
09:30 - 10:30
Inteligencia artificial: de dónde viene y hacia dónde vamos
Genís Roca, fundador, Consultoría RocaSalvatella
11:00 - 11:30
Inteligencia sensorial aplicada a las marcas
Camil Castella, Founding Partner, Aktiva Brand Experince Design
12:30 - 13:00
Certificados de la AEMPS sobre productos cosméticos
Cristina Dueñas, jefa de Servicio de Instalaciones de productos cosméticos, AEMPS; María Luisa Betés, jefe de Servicio de Comercio Exterior y certificados de exportación, AEMPS
13:00 - 13:30
Cosmile Europa, nueva base de datos sobre transparencia para el consumidor
Pilar García, directora Técnica, STANPA.
www.cosmetorium.es
ANQUE / UNICOOS
Campaña divulgativa sobre buenas prácticas en laboratorio
Demasiadas personas corren riesgos a diario, desde los laboratorios hasta la industria de todos los sectores, y comprender el producto químico y saber manipularlo es la mejor manera de evitar cualquier riesgo.
Por esta razón, en ANQUE piensan siempre en las mejores maneras de favorecer al sector químico, en este caso, centrán-
dose en crear contenido divulgativo en formato vídeo para concienciar a las empresas sobre la seguridad frente accidentes químicos.
En el video titulado “Buenas prácticas en Laboratorios”, David Calle ha visitado las instalaciones del CENIEH (Centro Nacional de Investigación sobre la Evolución Humana) en Burgos, sitio puntero
en la investigación científica y muy comprometido con la seguridad y la salud de sus trabajadores.
Unas buenas prácticas en el laboratorio pueden ayudar a prevenir accidentes, y más específicamente accidentes en los que se vean involucrados productos químicos capaces de causar una lesión química, es decir, corrosivos o irritantes.
técnicas de LABORATORIO 530 Nº 484 SEPTIEMBRE 2023
noticias
EMPRESAS
Carburos Metálicos abre su planta de producción de hidrógeno a estudiantes de máster
Carburos Metálicos, compañía del sector de gases industriales y medicinales en España que forma parte del grupo Air Products, recibió a primeros de julio, en su planta HyCO (Tarragona) la visita de un grupo de más de 20 estudiantes del Máster Interuniversitario de Formación Permanente en Tecnologías de Hidrógeno de las universidades Politècnica de Catalunya (Barcelona) y Rovira i Virgili (Tarragona), quienes conocieron de primera mano una de las plantas que la compañía tiene dentro del mayor polo petroquímico del sur de Europa.


Acompañados por el director de la planta HyCO, Jamie Nicoll, el grupo de estudiantes recibió información sobre el proceso de producción de hidrógeno, el llenado de las plataformas de hidrógeno, así como sobre la captura de CO2. Se trata de una oportunidad casi única para que estos estudiantes puedan conocer de cerca la producción del hidrógeno, un vector energético que tendrá un papel decisivo en la descarbonización de la industria y el transporte pesado de aquí a 2050.
El grupo de estudiantes que participó en la visita cursa el Máster Interuniversitario de Formación Permanente en Tecnologías de Hidrógeno, un título diseñado y avalado por cinco universidades y seis centros formativos y de investigación[1], entre ellos la Universitat Politècnica de Catalunya y la Universitat Rovira i Virgili. Los objetivos de este título son dotar al alumnado de las competencias necesarias para convertirse en profesionales capaces de desarrollar, gestionar y liderar las tecnologías del hidrógeno y sus aplicaciones, una especialidad alineada con las estrategias europeas de descarbonización y el impulso al sector industrial del hidrógeno. El grupo Air Products tiene entre sus líneas estratégicas el im-
pulso a la tecnología del hidrógeno para la industria y la movilidad en línea con su objetivo de sostenibilidad ‘Third by ‘30’, con el fin de reducir un tercio la intensidad de sus emisiones de CO2 para 2030. La compañía enmarca esta visita en las actividades que realiza dentro del eje ‘Cuidar’ de su política de sostenibilidad. Dicho eje contempla, entre otros aspectos, la respuesta a las necesidades de las comunidades en las que opera. “Como especialista en toda la cadena de valor del hidrógeno, Carburos Metálicos (…) tiene la capacidad y los conocimientos para producir, transportar y llevar el hidrógeno hasta cualquier dispositivo o vehículo que lo precise. Estamos encantados de compartir esta experiencia con el mundo académico para mostrar a los futuros profesionales las tecnologías relacionadas con el hidrógeno”, comentó Miquel Lope, director General de Carburos Metálicos y vicepresidente Sur de Europa y el Magreb de Air Products.
[1] Máster avalado por las universidades Politècnica de Catalunya, Rovira i Virgili, Mondragón, País Vasco y Zaragoza, y por seis centros formativos y de investigación: el Centro Integrado de Formación Profesional Somorrostro, el Centro de Formación Profesional Comte de Rius, el Institut Escola del Treball, el Centro Público Integrado de Formación Profesional Pirámide, la Fundación del Hidrógeno en Aragón y la Escuela de Organización Industrial.
En este vídeo podremos comprender algunas medidas preventivas, así como la actuación en caso de accidente, para lo cual se agradece el asesoramiento prestado por la empresa Prevor, en su calidad de especialista en riesgo químico. ¡No se lo pueden perder!
www.anque.es
técnicas de LABORATORIO 531 Nº 484 SEPTIEMBRE 2023
noticias
EMPRESAS
Relevo en la dirección Ejecutiva de Azbil Telstar
Telstar ha anunciado los nombramientos de Jordi Puig como CEO y de Emili Pablos como vicepresidente Ejecutivo y CFO de la empresa. Jochen Dick, actual CEO de la compañía, se centrará en su rol de vicepresidente no ejecutivo del Consejo de Administración de Azbil Telstar. Ambos nombramientos, en vigor desde el 31 de julio, han llegado tras un proceso de transformación de 10 años desde la integración de Telstar en azbil Group. El nombramiento de Puig y Pablos como directores Generales de Azbil Telstar en abril de 2022 marcó el inicio del proceso de transición hacia una nueva estructura de gobierno corporativo y dirección ejecutiva interna del negocio. La decisión se tomó tras evaluar el impacto positivo del proceso de transformación de Telstar en su integración en la estructu-
ra de gobierno corporativo de azbil Group desde 2013, cuando Telstar pasó de una estructura familiar a una estructura de gobierno corporativo de una empresa cotizada. Este proceso lo lideró Dick desde 2017 para reforzar la posición estratégica global de la empresa y garantizar un crecimiento sostenible a largo plazo.
Tras el proceso de adquisición llevado a cabo por azbil Group en 2013, Azbil Telstar ha liderado la división de negocio de Life Science Engineering de la corporación japonesa para proporcionar soluciones globales de alta tecnología en procesos de diseño, ingeniería y fabricación con tecnologías de automatización para los mercados internacionales de ciencias de la vida. A lo largo de 10 años de proceso transitorio de integración, la marca Telstar ha consolidado su repu-
tación siendo reconocida como uno de los 10 principales proveedores internacionales para la industria farmacéutica, presente en más de 100 países a través de sus 11 filiales en todo el mundo.
- Azbil Telstar. Telstar es una marca global líder en soluciones de procesos asépticos. Parte de azbil Group, la empresa está especializada en el desarrollo de proyectos de alta complejidad tecnológica, desde equipos de proceso integrados hasta el diseño, ingeniería y construcción de instalaciones completas de producción farmacéutica y biotecnológica llave en mano, instalaciones críticas, salas limpias y laboratorios de I+D. Telstar invierte el 3% de su facturación en I+D+i de sus tecnologías y equipos. Opera en más de 100 países y cuenta con 4 plantas de producción, 6 centros
COMPANIES
EMBL and Zeiss enter long-term strategic partnership
The European Molecular Biology Laboratory (EMBL) and Zeiss have entered a long-term strategic partnership. The collaboration aims to close the gap between early-stage imaging technology development and its application in life science research.

Through this collaborative approach, users of the EMBL Imaging Centre and related EMBL imaging services will have access to the latest microscopy technologies and expertise from Zeiss. At the same time, the research carried out at EMBL and projects by Imaging Centre users will provide Zeiss with invaluable insights into new applications and opportunities for market-testing their most recent technology developments. The new agreement, negotiated with support from EMBL’s technology transfer arm EMBLEM, is based on the long-term collaborative interaction between EMBL and Zeiss and previous project-based partnerships. For example, Zeiss recently supported the initial equipment for operations in the EMBL Imaging Centre and provided microscopy instruments for the EMBL mobile laboratories for field research.
“EMBL and Zeiss have been working together fruitfully on multiple microscopy projects for decades, and we are excited to take the next step in our relations and give it a strategic perspective in this new framework agreement,” commented
Michael Albiez and Edith Heard (Director General EMBL);
Front row, from
Herbert Schaden (Head of Global Academia Key Account Management at Zeiss Research Microscopy Solutions), Horst Wolff (Head of Light Microscopy at Zeiss Research Microscopy Solutions), Stephanie Alexander (Research & Service Coordinator, EMBL IC and Cell Biology & Biophysics), Jan Ellenberg, Rainer Pepperkok (Director of Scientific Core Facilities and Services at EMBL), Jürgen Bauer (Deputy Managing Director EMBLEM)
técnicas de LABORATORIO 532 Nº 484 SEPTIEMBRE 2023
noticias
left:
back row, from left:
de excelencia tecnológica y 10 centros de ingeniería y de consultoría y oficinas comerciales en todo el mundo. Tiene plantas de fabricación en España, China y Reino Unido. Con sede en Terrassa (Barcelona), cuenta con un equipo profesional de 1.000 personas. - Azbil. Azbil es el grupo japonés líder en automatización de edificios para el mercado de la construcción, automatización avanzada para el sector industrial y sistemas de automatización orientados al mercado de las ciencias de la vida y de la salud, así como los ámbitos estrechamente vinculados con la vida cotidiana. El grupo desarrolla sus propias tecnologías, equipos y sistemas de regulación, control y automatización industrial y de edificios. Como filial de Azbil, Telstar lidera la división
Jan Ellenberg, Head of the EMBL Imaging Centre. The long-term collaboration will allow the users of the Imaging Centre to get early access to the latest microscopy innovations from Zeiss. At the same time, regular strategic discussions

Life Science Engineering de la corporación japonesa para proporcionar soluciones globales en diseño, ingeniería y procesos de fabricación con tecnologías de automatización para los mercados internacionales de las ciencias de la vida, como el biofarmacéutico, la investigación en ciencias de la vida, medicina personalizada, la medicina regenerativa y alimentos funcionales. El grupo Azbil, que cotiza en la bolsa de Tokyo, fue fundado en 1906 y hoy cuenta con un equipo profesional consolidado de 10.063 personas y una cifra de negocio que fue de 278,4 millones de yenes en FY2022 (31/03/2023).
www.telstar.com
(Véase anuncio en la sección Guía del Comprador.)
will provide a unique opportunity for EMBL and Zeiss to engage in joint technology development, thereby making sure life scientists’ future needs for imaging technologies are considered for the development of the next generation of commercial microscopes.
The EMBL Imaging Centre’s core mission is to provide access to and training in cutting-edge imaging technologies and to stimulate the ongoing development of these technologies. This offers a unique opportunity to take the partnership with Zeiss to a new level.

Michael Albiez, Head of Zeiss Research Microscopy Solutions, stated: “This collaboration is creating new ways for both EMBL and Zeiss to interact and work together. The cutting-edge research performed in the EMBL Imaging Centre and EMBL will be an ideal testing and development environment for our next generation of imaging technologies.”
EMBL and Zeiss work together to make new technologies available as early as possible to users of the Imaging Centre and related EMBL services and thereby guide their development for future applications in the life sciences. The collaboration focuses on three areas: the joint development and application testing of new imaging technologies, joint activities in Open Data, and training.
técnicas de LABORATORIO 533 Nº 484 SEPTIEMBRE 2023
noticias
Anna Steyer, Cryo-tomography Specialist at EMBL IC explains service workflows offered in correlative light and electron microscopy under cryogenic conditions to Albiez and Schaden
Jordi Puig
noticias
SOFTTEK
La inteligencia artificial aplicada, lista para abordar tareas corporativas
La IA aplicada hace referencia al uso práctico y eficaz de la inteligencia artificial para impulsar la eficiencia de los procesos empresariales. Su foco está en crear sistemas y tecnologías que se puedan emplear en una amplia gama de aplicaciones, desde la automatización de tareas repetitivas hasta la toma de decisiones avanzadas y el análisis de datos en tiempo real.
Como empresa tecnológica global, Softtek destaca que la IA aplicada combina tecnologías y métodos, como el aprendizaje automático, la visión por ordenador, el procesamiento del lenguaje natural y el modelado de datos. En definitiva, es el puente que conecta experimentación y producción en el campo de la inteligencia artificial, poniendo a tra-
bajar la parte teórica de la IA para que se convierta en una realidad tangible desde una perspectiva empresarial.
En el terreno de la IA aplicada, uno de sus principios clave es “hacerlo sencillo”, lo que implica simplificar el uso de las herramientas de inteligencia artificial y su aplicación. Según la expansión de las plataformas de low-code/no-code en los campos de la IA y el aprendizaje automático es crucial para facilitar la implantación de estos sistemas en más organizaciones y popularizar el uso de sus capacidades avanzadas. La aplicación de la IA en el mundo empresarial representa un paso más hacia la transformación en curso del trabajo, lo que se conoce como la cuarta revolución industrial. Sin embargo, aunque sus
efectos disruptivos aún no se pueden medir, sí permiten vislumbrar un futuro donde máquinas y humanos trabajarán de manera conjunta para alcanzar una mayor eficiencia y productividad. Como consecuencia de la hiperconectividad, la IA aplicada permitirá procesar los datos que generan los dispositivos para tomar decisiones estratégicas en las empresas, lo que transformará las funciones, la organización interna y los cargos de responsabilidad dentro de las organizaciones. Los sistemas inteligentes, basados en ‘Large Language Models’, permitirán analizar los datos conectados y ofrecer respuestas en tiempo casi real, proporcionando información precisa y dando a las máquinas un papel clave en los procesos internos.
ANQUE
Green Management Technology, nuevo socio institucional
La Asociación Nacional de Químicos e Ingenieros Químicos de España (ANQUE) y GreeMko, compañía que nace con la misión de facilitarle a las empresas su camino hacia la sostenibilidad ambiental y la descarbonización, han suscrito un convenio de colaboración por el que esta última adquiere la condición de socio institucional de ANQUE, que supondrá, entre otras cosas, mantener informados a todos los miembros sobre las novedades que se produzcan en este ámbito.

El software desarrollado por GreeMko facilita la certificación en gestión ambiental ISO 14001 y el cálculo de la huella de carbono (Alcance 1, 2 y 3). Es el software más sencillo del mercado ya que, gracias a la digitalización y su algoritmo, permite capturar automáticamente todos los datos necesarios para hacer una gestión ambiental activa y calcular automáticamente la huella de carbono de una forma eficiente y trazable
facilitando así el proceso de auditoría.
El software de GreeMko ha sido verificado bajo el estándar del GHG Protocol siguiendo las directrices de cálculo de IPCC (International Panel on Climate Change), para el cálculo de huella de carbono de los Alcances 1, 2 y 3. Además, cumple los requisitos de cálculo, monitorización y trazabilidad de la información requeridos por la norma ISO 14064-1:2018. GreeMko ofrece diferentes planes según las necesidades de la empresa, ya sean empresas que estén comenzando o firmas que ya estén trabajando en esta área. El software, entre otras funcionalidades, permite analizar la información, establecer comparativas según diferentes criterios y establecer objetivos de mejora continua. Gracias a GreeMko las empresas pueden, de una forma más sencilla, cumplir con una normativa cada vez más exigente, ser más competitivas en licitaciones públicas gracias al registro en el Ministerio para la Transición Ecológica y el
Reto Demográfico, homologarse como proveedores en grandes empresas, reducir costes, acceder a nuevas formas de financiación como préstamos verdes, posicionar su marca, atraer y retener talento, apoyar acciones de marketing y, por supuesto , elaborar un plan de reducción del impacto ambiental y alinearse con los Objetivos de Desarrollo Sostenible.
El equipo, la digitalización y ser una solución integral para todos los aspectos ambientales son algunos de los elementos diferenciadores. GreeMko es una empresa de impacto 100% española.
técnicas de LABORATORIO 534 Nº 484 SEPTIEMBRE 2023
Así, las máquinas podrán influir en la toma de decisiones como el establecimiento de los precios, la gestión de riesgos, la optimización de procesos, la personalización de ofertas y la mejora de la atención al cliente, lo que cambiará para siempre la manera en que las empresas operan y cómo las personas interactúan con las máquinas. A medida que la tecnología avance en su proceso evolutivo, lo más probable es que aumente la aceptación y el uso de la IA aplicada en diferentes ámbitos como la gestión financiera y de inversiones. Esta comoditización plantea esta pregunta: ¿cómo pueden diferenciarse las empresas en un mercado en el que la información se procesa en tiempo real? La clave reside en una colabora-
noticias
ción estrecha entre los humanos y las máquinas, una capacidad determinante de los equipos humanos para interpretar correctamente la información procesada por las máquinas. Para un empleo efectivo de la IA, son necesarios tres pilares clave: innovación tecnológica, estrategia empresarial y cultura organizativa. “Estamos siendo testigos de un avance sin precedentes en el apartado de la inteligencia artificial. Un ejemplo de estos Large Lenguage Models es ChatGPT. Están en nuestro día a día y nos ayudan a tomar decisiones. La cuarta revolución industrial ya está aquí. En esta nueva era será más necesario que nunca que los equipos humanos interpreten adecuadamente la información procesada por las máquinas. De esta manera, las organizaciones po-
drán transformar e impulsar la eficiencia hasta niveles desconocidos hasta la fecha. La IA aplicada ha llegado para quedarse y ya está preparada para tomar decisiones importantes”, dice Gema Ruiz, Head of AI & Data en Softtek.
Fundada en 1982 por un pequeño grupo de emprendedores, Softtek comenzó en México proporcionando servicios de TI locales y hoy destaca en soluciones digitales de próxima generación. Primera compañía en introducir el modelo Nearshore, Softtek ayuda a las empresas Global 2000 a desarrollar capacidades digitales de manera fluida y constante, desde la ideación y construcción hasta la ejecución y su evolución. Su impulso emprendedor la ha llevado a operar en más de 20 países y contar con más de 15.000 profesionales.
GreeMko tiene ya clientes como Siemens Energy, Selenis, Evertis, Grupo Giró, Metrovacesa, González Byass, OHLA, Grupo Noatum, AXA Seguros, Forética y otras empresas de diferentes sectores y tamaños. Ha sido también la adjudicataria de la licitación pública del reto de sostenibilidad de RENFE Trenlab. Green Management Technology GreeMko (www. greemko.com) es una empresa emergente que ha diseñado una herramienta para la medición y análisis de las emisiones y desempeño ambiental de entidades, y facilita a sus clientes su camino hacia la sostenibilidad ambiental y la descarbonización. Es una solución SaaS (Software as a Service) en que, gracias a la digitalización, no hace falta introducir los datos a mano, una solución integral para gestionar todos los aspectos ambientales incluida la huella de carbono de Alcance 1, 2 y 3.
www.anque.es
ANQUE
Colaboración oficial en el I Congreso Nacional del Hidrógeno Verde
La Asociación Nacional de Químicos e Ingenieros Químicos (ANQUE), es colaboradora oficial del I Congreso Nacional del Hidrógeno Verde, organizado por la Federación Onubense de Empresarios, que tendrá lugar en Huelva los días 7 y 8 de febrero del próximo año.
El presidente de ANQUE, Ernesto Castañeda, ha sido invitado a formar parte del Comité de Honor cuya presidencia ostenta SM el rey Felipe VI. Castañeda ha destacado la importancia de que este encuentro aglutine a la gran industria del sector del hidrógeno verde y que cuente con la industria química, gran consumidora de hidrógeno en todos sus procesos.
En el Congreso se expondrán temas relacionados con los avances y el desarrollo del hidrógeno verde. Se ha desarrollado una agenda según las siguientes cuestiones:
• Recursos: electricidad, agua, electrolizadores
• Industria química: fabricación de H2, combustibles sintéticos con H2 verde, portadores de H2, metanol, fertilizantes verdes
• Sector del transporte con H2 verde o derivados; terrestre, aéreo, marino
• Sector del acero y cemento
• Industria auxiliar
• Logística, almacenamiento y distribución
• Normativa y formación
www.anque.es
técnicas de LABORATORIO 535 Nº 484 SEPTIEMBRE 2023
noticias
WASSERLAB
Exportación y ferias Internacionales
Wasserlab continúa creciendo tanto a escala nacional como internacional. Con más de 2.000 equipos vendidos en España, consolida su posicionamiento y ofrece al mercado una alternativa de calidad, involucrándose al máximo con sus clientes en proporcionar soluciones a sus necesidades.
En lo que respecta al mercado internacional, continúa con su crecimiento sostenido dando servicio en más de 60 países.
Wasserlab venía manteniendo un equilibrio en el volumen de fabricación de equipos para los mercados nacional e internacional. No obstante, en los últimos ejercicios, la empresa está centrando una parte de sus recursos en fomentar el crecimiento del mercado internacional, a fin de que este adquiera paulatinamente un mayor peso en los resultados.
El potencial de la exportación a otros países es claramente superior a la cuota que representa el mercado nacional. Con esta idea se afrontó la participación en ferias internacionales del sector, dando a conocer a Wasserlab y ampliando la presencia
de la firma más allá del mercado local.
En 2018 Wasserlab estuvo presente en la feria Achema de Frankfurt como expositor, siendo esta experiencia un claro indicador del camino que había que seguir en los años venideros. La presencia en la siguiente feria estaba planificada y confirmada para el 2022, pero la pandemia y la inestabilidad añadida por el conflicto de ese mismo año, hicieron que se decidiera cancelar. Entre los mercados objetivo de la empresa destaca Oriente Medio. Es una de las zonas donde la empresa ha tenido mayor crecimiento en los últimos años, confirmando el potencial del sector en los países de dicha área.
Con el objetivo de consolidarse aún más en el mercado de Oriente Medio, Wasserlab asistirá como expositor en la feria ArabLab (Dubai) en septiembre, ofreciendo nuevas soluciones y productos. De esta forma la marca vuelve a estar presente en una feria internacional donde podrá seguir trabajando y afirmando su crecimiento.
www.wasserlab.com
(Véase anuncio en la sección Guía del Comprador.
COMPANIES
Trescal acquires Unithree to consolidate market in South Korea
Trescal announced that it has acquired Unithree to open operations in Busan, Korea’s largest port. This brings Trescal’s Korean operations to 40M EUR and 330 people over six locations. This is the first acquisition since EQT acquired a majority stake in Trescal this year.
Founded in 2011 and merged with KCDI in 2018, Unithree represents 2M EUR in sales and employs 25 people. It performs accredited calibrations in several domains. Its dimensional, force and balance capabilities will complement Trescal’s Korean technical expertise in the southern part of the country. Unithree serves a diverse client

base in the automotive, shipbuilding, energy and metal forging industries.

Guillaume Caroit, Trescal CEO: “We are delighted to welcome Unithree to the Trescal family. Under EQT, we will continue to expand in the thriving Asian market as we aim to achieve 300M in regional sales by the end of 2027.”
Trescal is a global specialist in calibration services. It offers an array of industries a single-source solution for calibration, measurement, repair, qualification, validation and asset management across the globe. Its technicians and experts carry out accredited and non-accredited services for all measured variables and
measuring instruments in all technical domains. About 5,000 people work at Trescal around the world to perform 3.3 million operations per year, including 27,000 repairs across 150,000 types of instruments and 20,000 brands.

técnicas de LABORATORIO 536 Nº 484 SEPTIEMBRE 2023
FORMACIÓN
noticias
Scharlab organiza el 20 de septiembre, en Farmaforum / Labforum, en Madrid, dos talleres. El primero presentará el muestreador de aire volumétrico Holbach y se dedicará a la medición microbiológica en superficies y aire según la normativa vigente. El segundo versará sobre la valoración Karl Fischer de la mano
Medición microbiológica en superficies y aire según UNE-EN 17141, ISO 14644, ISO 14698 y GMP


Horario: 12.00-13.00
Ponentes: Xavi Torralba (Microbiology Product Specialist) y Mireia (Ortí Product Manager Consumable & Instrumentation).
El aseguramiento del control microbiológico en superficies y en el aire es esencial en el ámbito farmacéutico. Varias normas internacionales como UNE-EN 17141, ISO 14644, ISO 14698, y GMP describen directrices y requisitos para el control de biocontaminación en salas limpias y ambientes controlados. El objetivo del taller es proporcionar las herramientas necesarias para llevar a término la correcta medición microbiológica en superficies y en el aire, según las normas internacionales, con los medios de cultivo Scharlau y el muestreador de aire volumétrico de la nueva marca distribuida Holbach.
de Metrohm, empresa líder en la fabricación de estos equipos. Ambos talleres se realizarán dentro de la feria Labforum/Farmaforum. Si necesita invitación a la feria, escriba a consultas@ scharlab.com. Las plazas son limitadas, se respetará el orden de inscripción y se entregará certificado de asistencia.
Valoración Karl Fischer en un nivel completamente nuevo
Horario: 13.00-14.00
Ponentes: Arantxa de la Iglesia (jefe de Producto Metrohm Titration) y Mireia Contreras (Product Manager Chemicals & Chromatography).
Reserve su plaza aquí:
Talleres Scharlab en Labforum www.scharlab.com
La valoración Karl Fischer es el método globalmente aceptado para la determinación de agua desde principios del siglo XX. Con las nuevas formulaciones Aquagent® se consigue un factor más estable y robusto, una estabilización más rápida, una mayor velocidad de reacción y un punto final más estable. La nueva línea de reactivos para Karl Fischer Aquagent® Scharlau se integra perfectamente con los equipos Karl Fischer Metrohm.
Los valoradores Karl Fischer Metrohm permiten la determinación de agua de forma rápida y precisa, con un manejo seguro, sencillo e intuitivo. Junto con el nuevo electrodo de doble anillo de platino, único en el mercado, que aporta una gran robustez, permiten un trabajo sin contacto con los reactivos y el total cumplimiento de las normativas GLP y 21 CFR Part 11.

Reserve su plaza aquí:

técnicas de LABORATORIO 537 Nº 484 SEPTIEMBRE 2023
(Véase anuncio en la sección Guía del Comprador.)
La Entidad Nacional de Acreditación (ENAC) ha concedido a la Sociedad Española de Medicina de Laboratorio (SEQCML) la primera acreditación como proveedor de programas de intercomparaciones de índices séricos. La sociedad ya tenía 8 programas de intercomparación acreditados en bioquímica y este programa se presenta como un complemento adicional que permite evaluar la calidad de las muestras, por lo que tiene un gran impacto en la calidad y la fiabilidad de los resultados de las pruebas de laboratorio.
La Dra. Andrea Caballero, presidenta de la Comisión de Extraanalítica y miembro del Comité de Programas Externos de la Calidad de la SEQCML analiza la principal diferencia de este programa con otros acreditados en bioquímica ofrecidos por la SEQCML: “La presencia de hemólisis (H), ictericia (I) y lipemia (L) en las muestras son una interferencia común y frecuente en muchos test de laboratorio. Por eso, la mayoría de los laboratorios ya han adoptado la evaluación de la calidad de la muestra antes de la determinación de los analitos como parte de su práctica rutinaria mediante la determinación de los índices HIL, además, de manera automatizada, reemplazando a la inspección visual realizada en el pasado”.
La Dra. Caballero apunta que esta medida “tiene que ser estable y precisa a lo largo del tiempo, pero la mayoría de los laboratorios no tienen en cuenta la comprobación del desempeño del módulo de medida HIL”. Asimismo, señala que “los índices séricos no suelen aparecer en los informes de resultados como tales y, sin embargo, condicionan la entrega de otras pruebas; por tanto, deberían estar sujetos a procedimientos de control de la misma manera que el resto de las pruebas del laboratorio, sometidas a controles de calidad internos y programas de garantía externa de la calidad”. Por ello, destaca que “los programas de intercomparación son, en la mayoría de los casos, la única manera que tienen los laboratorios de controlar el funcionamiento de la medida de dichos índices, por la falta de uso y/o disponibilidad de controles internos de calidad”.
Por su parte, la Dra. Berta Piqueras, codirectora de la SEQCML y miembro del Comité de Programas Externos de la Calidad de dicha sociedad, recalca que “participar en programas de intercomparación acreditados es fundamental para detectar posibles errores o desviaciones del comportamiento habitual de los métodos de medida de los índices séricos y consecuentemente identificar áreas de mejora del laboratorio para obtener resultados analíticos fidedignos que permitan confirmar o descartar un diagnóstico clínico o realizar un correcto seguimiento, garantizando la seguridad del paciente”.
“El objetivo principal del programa acreditado de índices séricos es promover conocimientos entre sus participantes que contribuyan a aumentar la calidad de los resultados analíticos generados en sus laboratorios, controlando la calidad de las muestras y, por lo tanto, la fase preanalítica. Asimismo, permite valorar la imprecisión a largo plazo por parte del partici-
pante y el error sistemático entre los grupos de los diferentes instrumentos”.

Con respecto al valor que aportan los servicios de intercomparación acreditados a la calidad diagnóstica y al paciente, la Dra. Piqueras apunta que “en la mayoría de los laboratorios los índices séricos se están utilizando para no entregar los resultados de determinados analitos o la entrega con un comentario que indique la desviación que el índice puede estar ocasionando; es decir, se utilizan para tomar decisiones que implican la disponibilidad o no de los resultados para el clínico”. En este sentido, explica que “la acción de no entregar un resultado puede tener consecuencias graves sobre el manejo del paciente, ya que la obtención de una nueva muestra prolonga los tiempos de respuesta y, por lo tanto, puede retrasar el diagnóstico y/o el tratamiento”.
La Dra. Andrea Caballero añade que “los índices séricos no solo son magnitudes utilizadas para evaluar la calidad de las muestras, sino que cada vez más se usan como magnitudes con relevancia clínica propia: el índice de hemólisis como marcador de hemólisis intravascular, el índice de ictericia como marcador del nivel de bilirrubina sérica y el índice de turbidez como marcador de presencia de un posible componente monoclonal”. Por todo ello “es importante evaluar su desempeño mediante la participación en un programa de intercomparación acreditado como es el de la SEQCML”, concluye.
La calidad y la seguridad son dos elementos fundamentales para garantizar un sistema sanitario acorde con las necesidades actuales. La acreditación de ENAC proporciona confianza en los diferentes ámbitos y etapas de la prestación de los servicios siendo un sector en el que cada vez se hace más uso de la acreditación como instrumento de seguridad y control. ENAC ha acreditado a laboratorios de muy diversas especialidades (inmunología, bioquímica, genética, microbiología, hematología, anatomía patológica) y de diferentes niveles de especialización, desde centros nacionales de referencia a laboratorios hospitalarios de rutina y de urgencias, tanto públicos como privados.
técnicas de LABORATORIO 538 Nº 484 SEPTIEMBRE 2023
noticias
ENAC
La SEQCML, acreditada como proveedora de ensayos de aptitud de índices séricos
FERIAS
Expositores y visitantes avalan el éxito de Expoquimia 2023
La edición de 2023 de Expoquimia, el Encuentro Internacional de la Química de Fira de Barcelona, superó las expectativas tanto de expositores como de visitantes, quienes expresaron su apoyo al encuentro, según las encuestas de opinión presentadas en la reunión de cierre de su comité organizador. Tanto es así que 79% de las empresas expositoras afirma haber cubierto sus objetivos mientras que los visitantes puntúan con un 3,70 sobre 5 su grado de satisfacción.

Este año, Expoquimia, con Equiplast, el Encuentro Internacional del Plástico y el Caucho, reunió un total de 18.784 visitantes, un 8% de ellos internacionales, destacando la presencia de asistentes de Portugal (26%), Italia (16%), Alemania (10%) y Francia (8%). En cuanto a la distribución por comunidades autónomas, el 69% de los visitantes procedieron de Cataluña; el 7% de la Comunidad Valenciana y el 6,5% de Madrid. La elevada calidad de los visitantes fue una de las principales características de la edición de este año, ya que el 16% fueron consejeros delegados y el 8%, directores de área de sectores como el químico, el agroquímico, la perfumería, la cosmética o el farmacéutico.
En cuanto a los motivos de asistencia, relacionarse con otros profesionales, conocer nuevos productos, proveedores y soluciones para futuras referencias fueron los más citados entre los visitantes.
En este sentido, los encuestados expresaron su satisfacción con la calidad de los expositores (un 3,73 sobre 5) y con la organización del salón (3,95). Presidido por el director General de BASF Española y vicepresidente de la Federación Empresarial de la Industria Química Española (FEIQUE), Carles Navarro, en el comité organizador de clausura de esta edición que reunió a un total de 276 expositores, un 21% internacionales, se analizaron otros datos.
Así, un 79% de las empresas participantes manifestaron haber cubierto sus expectativas. Un 15% de ellas afirmó haber cerrado acuerdos comerciales en el marco del salón mientras que un 27% dijo haber iniciado contactos que se cerrarán a lo largo de los próximos meses. El grado de satisfacción es muy elevado (3,69), lo que hace que el 60% de los expositores manifieste su intención de volver a Expoquimia en su próxima edición, que será en 2026.
En la reunión del comité también se hizo balance de las actividades organizadas en el marco del salón como el ‘Industry Showcase’, en el que representantes de los sectores usuarios de las soluciones de la industria química dieron a conocer sus experiencias; el programa ‘Best in class’, que premió las iniciativas disruptivas e innovadoras de H2Site, Inditex, Repsol y Fuelium; Smart Chemistry, Smart Future, iniciativa liderada por FEIQUE, que contó con 16 entidades participantes y 52 po-
nentes; el Congreso Mediterráneo de Ingeniería Química, con 289 asistentes y un 22% de empresas participantes; el Tech Transfer & Innovation Area o diversas sesiones y jornadas como las de Acció, el Beauty Cluster o la Asociación Española de Profesionales de Compras, Contratación y Aprovisionamientos (AERCE).

La reunión del Comité fue además la ocasión ideal para entregar al presidente emérito Dr. Rafael Foguet, como recoge una de las fotos, un reconocimiento especial, como se adelantó en la primera edición de la Gala Dinner de Expoquimia, que reunió a más de 600 representantes de las principales empresas del sector en la Sala Oval del Museu Nacional d’Art de Catalunya. Para finalizar, tanto el presidente Carles Navarro como el director Xavier Pascual apuntaron algunos retos a los que tiene que hacer frente el salón ante sus próximas ediciones de 2026 y 2029, entre los cuales destacaron la necesidad de incrementar la oferta expositora para así poder ser más representativos, aumentar el grado de internacionalidad y lanzar una apuesta más decidida por la sostenibilidad como gran eje temático del salón.
www.expoquimia.com
técnicas de LABORATORIO 539 Nº 484 SEPTIEMBRE 2023
noticias
noticias
AMSBIO
Exploring neurodegenerative diseases in microgravity
AMSBIO, a leading supplier of human cell lines and research tools, has announced its collaboration with WARR Space Labs, a student group from the Technical University of Munich (TUM). The students undertook an exciting project aimed at advancing our understanding of neurodegenerative disorders, particularly Alzheimer’s disease, through spaceborne experiments.
The aim of the ADDONISS (Ageing and Degenerative Diseases of Neurons on the ISS) project is to conduct research on neuronal cell cultures in the microgravity environment of the International Space Station (ISS). AMSBIO’s contribution to this groundbreaking endeavour includes providing the SH-SY5Y/GFP stable cell line and contributing EUR 1,000 towards the team’s funding costs while they were conducting research at the NASA laboratories.
Selina Kanamüller, a member of WARR Space Labs student team at TUM, said: “The experience of getting to conduct research in NASA laboratories has been unforgettable. Thanks to the help of AMSBIO and our extensive preparations for more than a year, everything went well.” On the 15th of March, the experiment was successfully taken to the ISS using the SpaceX Falcon 9 launch vehicle. The WARR Space Labs team is currently evaluating the data gathered from the

experiment. As the team awaits the results of the ADDONISS project, there is great anticipation for the potential contribution it may bring to Alzheimer’s research and the broader field of neurodegenerative disease research. AMSBIO is a leading international supplier of ready-to-use human cell lines including receptor, ion channel, cell signalling, phosphodiesterase, and CRE recombinase lines. The company’s cell lines are extensively validated to ensure that they provide you with the best quality products to support your research.
To read an extended length blog about AMSBIO’s cooperation with the ADDONISS project please visit https://
www.amsbio.com/news/cells-in-space
Founded in 1987, AMS Biotechnology (AMSBIO) is recognized today as a leading transatlantic company contributing to the acceleration of discovery through the provision of cutting-edge life science technology, products, and services for R&D in the medical, nutrition, cosmetics, and energy industries. AMSBIO has indepth expertise in extracellular matrices to provide elegant solutions for studying cell motility, migration, invasion, and proliferation. This expertise in cell culture and the ECM allows AMSBIO to partner with clients in tailoring cell systems to enhance organoid and spheroid screening outcomes using a variety of 3D culture systems, including organ-on-a-chip microfluidics. For drug discovery research, AMSBIO offers assays, recombinant proteins, and cell lines. Drawing upon a huge and comprehensive biorepository, AMSBIO is widely recognized as a leading provider of high-quality tissue specimens (including custom procurement) from both human and animal tissues. The company provides unique clinical grade products for stem cells and cell therapy applications. This includes GMP cryopreservation technology, and high-quality solutions for viral delivery.

técnicas de LABORATORIO 540 Nº 484 SEPTIEMBRE 2023
Ready to use stable cell lines (courtesy: AMSBIO)
The WARR Space Labs team from the Technical University of Munich (TUM)

guía del COMPRADOR A




guía del COMPRADOR A







guía del COMPRADOR B-C







guía del COMPRADOR C






guía del COMPRADOR D-E-F




guía del COMPRADOR E-F-G-H







guía del COMPRADOR H-I







guía del COMPRADOR I-J-K-L
DISEÑO, FABRICACIÓN, INGENIERÍA Y APLICACIONES ESPECIALES EN:

• CROMATOGRAFÍA DE GASES HRGC
• CROMATOGRAFÍA DE LÍQUIDOS HPLC y LC
• SISTEMA MULTIDIMENSIONAL HPLC+HRGC (Pat)


• SISTEMAS COMBINADOS HRGC-HPLC-DIP-MS

• ESPACIO DE CABEZA, P&T, SPME...
• LABORATORIO DE ANÁLISIS ESPECIALIZADOS




• CURSOS DE FORMACIÓN
Barcelona T +34.93.590.28.40 F +34.93.590.28.44 ventas@konik-group.com
Ma drid T +34.91.328.25.26 F +34.91.328.36.54 madrid@konik-group.com
Única compañía europea con gama completa de HRGC/HPLC/MS
guía del COMPRADOR L-M-N








guía del COMPRADOR N-O-P-Q-R








guía del COMPRADOR R-S






guía del COMPRADOR S-T





guía del COMPRADOR T-V-W